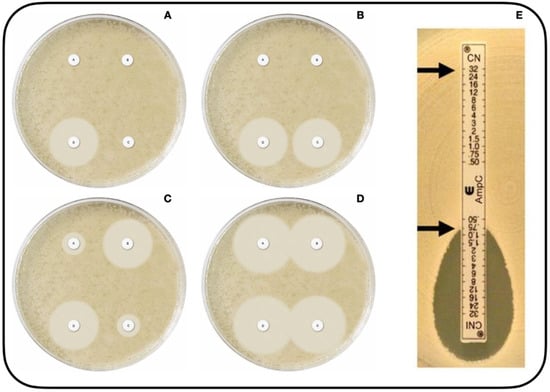
Microorganisms 10 00611 g001

Abstract
Beta-lactamase (BL) production is a major public health problem. Although not the most frequent AmpC type, AmpC-BL is increasingly isolated, especially plasmid AmpC-BL (pAmpC-BL). The objective of this study was to review information published to date on pAmpC-BL in Escherichia coli and Klebsiella pneumoniae, and on the epidemiology and detection methods used by clinical microbiology laboratories, by performing a systematic review using the MEDLINE PubMed database. The predictive capacity of a screening method to detect AmpC-BL using disks with cloxacillin (CLX) was also evaluated by studying 102 Enterobacteriaceae clinical isolates grown in CHROMID ESBL medium with the addition of cefepime (FEP), cefoxitin (FOX), ertapenem (ETP), CLX, and oxacillin with CLX. The review, which included 149 publications, suggests that certain risk factors (prolonged hospitalization and previous use of cephalosporins) are associated with infections by pAmpC-BL-producing microorganisms. The worldwide prevalence has increased over the past 10 years, with a positivity rate ranging between 0.1 and 40%, although AmpC was only detected when sought in a targeted manner. CMY-2 type has been the most prevalent pAmpC-BL-producing microorganism. The most frequently used phenotypic method has been the double-disk synergy test (using CLX disks or phenyl-boronic acid and cefotaxime [CTX] and ceftazidime) and the disk method combined with these inhibitors. In regard to screening methods, a 1-µg oxacillin disk with CLX showed 88.9% sensitivity, 100% specificity, 100% positive predictive value (PPV), 98.9% negative predictive value (NPV), and 98.9% validity index (VI). This predictive capacity is reduced with the addition of extended-spectrum beta-lactamases, showing 62.5% sensitivity, 100% specificity, 100% PPV, 93.5% NPV, and 94.1% VI. In conclusion, there has been a worldwide increase in the number of isolates with pAmpC-BL, especially in Asia, with CMY-2 being the most frequently detected pAmpC-BL-producing type of microorganism. Reduction in its spread requires routine screening with a combination of phenotypic methods (with AmpC inhibitors) and genotypic methods (multiplex PCR). In conclusion, the proposed screening technique is an easy-to-apply and inexpensive test for the detection of AmpC-producing isolates in the routine screening of multidrug-resistant microorganisms.
1. Introduction
The loss of susceptibility to beta-lactam antibiotics in Gram-negative bacteria is an emerging problem worldwide and is mainly attributable to the production of beta-lactamases, especially extended-spectrum (ESBL) and AmpC type (AmpC-BL) beta-lactamases and carbapenemases [1]. The CESPM group (Citrobacter freundii, Klebsiella aerogenes, Enterobacter cloacae, Serratia marcescens, Providencia stuartii, and Morganella morganii) comprises common Enterobacteriaceae species responsible for nosocomial and community infections produced by inducible chromosomal AmpC beta-lactamases. However, other more prevalent species in patients, such as Escherichia coli and Klebsiella pneumoniae, can present these enzymes with plasmid gene encoding (pAmpC-BL). There has been limited research on pAmpC-BL in comparison to the more frequently detected ESBL- and carbapenemase-producing microorganisms [1,2,3]. There has been no estimate of the true worldwide prevalence of pAmpC-BL-producing microorganisms [4], and no consensus on the most effective laboratory technique for their detection [5]. AmpC-BL-producing microorganisms can also be associated with other types of resistance, highlighting the coexistence of AmpC-BL and ESBL [3].
Colonization of the intestine and larynx may serve as an important reservoir for resistance genes [6,7] of the microorganisms that inhabit them, and can be a risk factor for infection. There is a need for simple, effective, easy-to-apply, and inexpensive techniques to screen for these pathogens in the digestive tract of infected or colonized patients. ESBL-producing Enterobacteriaceae colonies can be detected by various techniques, including the use of CHROMID ESBL (bioMérieux, France). This transparent medium contains cefpodoxime and other substances that inhibit Gram-positive bacteria growth, and chromogenic substrates that presumptively identify genera and species according to their color (pink/burgundy for E. coli; blue/green for Klebsiella, Enterobacter, Serratia, or Citrobacter; and light to dark brown for Proteae) [8]. The inclusion of cefoxitin (FOX), cefepime (FEP), and ertapenem (ETP) disks on CHROMID ESBL medium has been proposed for the presumptive identification of ESBL- and/or carbapenemase-producing microorganisms through their resistance to these antibiotics, and a halo diameter breakpoint of 16 mm has proven diagnostically useful [9]. However, the diagnostic performance can be further improved by the addition of other antibiotic disks to reveal the possible presence of AmpC-BL. The production of carbapenemase, ESBL, and AmpC-BL is frequently studied in episodes of colonization by multi-resistant Gram-negative bacteria, and the addition of ETP, FOX, FEP, and cloxacillin (CLX) disks to this medium may offer a simple and effective method for this purpose. CLX shows greater activity against AmpC-BL-producing Enterobacterales but lesser activity against carbapenemase- or ESBL-producing Enterobacterales or carbapenemase-producing Pseudomonas spp. and A. baumannii; hence, CLX disks may be useful to detect the presence of microorganisms with AmpC [10].
Tests using cultures for the detection of colonies of resistant microorganisms offer an advantage over PCR tests because they detect viable microorganisms and facilitate their recovery, avoiding their loss. Unfortunately, no commercial culture tests are available for the simultaneous detection of Gram-negative microorganisms with different mechanisms of resistance to β-lactam antibiotics. The objectives of the present study were: carry out a systematic review of epidemiological information on pAmpC-BL in K. pneumoniae and E. coli species; and evaluate the behavior of microorganisms with AmpC-BL in the ChromID® ESBL medium by using the disk diffusion test with FOX, FEP, ETP, and CLX disks.
2. Material and Methods
2.1. Systematic Review
The PubMed® database was searched using the search term “(AmpC [Title/Abstract]) AND (Plasmid [Title/Abstract])”. Review inclusion criteria were: (i) study on the conceptualization of AmpC type resistances; (ii) study on the epidemiology and clinical relevance of these resistances from 2010 onwards; and (iii) study on their detection. Exclusion criteria were: (i) study of isolation of bacterial species other than K. pneumoniae or E. coli; (ii) study of their isolation in food production chains, animals, farms, aqueous media, and other environmental settings; (iii) language other than English or Spanish; and iv) inability to access the text. The search yielded 1001 publications published up to 7 January 2021; 395 of these met the eligibility criteria, and 149 were finally included in the review.
2.2. Behavior of Enterobacteriaceae with AmpC-BL in ChromID® ESBL Medium, Using the Disk Diffusion Test with CLX Disks
A retrospective study was conducted in the Microbiology Department of our hospital in Granada (Spain), which covers a population of around 440,000 inhabitants. It included all Enterobacterales strains (67 from rectal swabs and 35 from urine cultures) detected during February 2021 with suspicion of colonization or urinary tract infection by ESBL or carbapenemase microorganisms in individuals aged >14 years). Species were grouped according to their resistance mechanisms, as defined by EUCAST 2021 criteria [11], finding: 47 with ESBL (25 E. coli, 19 K. pneumoniae, 1 C. freundii, 1 Proteus mirabilis, and 1 Klebsiella oxytoca); 39 with the carbapenemases oxacillinase (OXA) (16 K. pneumoniae, 11 E. cloacae, and 1 E. coli), Klebsiella pneumoniae carbapenemase (KPC) (6 K. pneumoniae), and Verona integron-encoded metallo-beta-lactamase (VIM) (5 K. pneumoniae); 9 with AmpC (5 M. morganii, 2 Kluyvera intermedia, 1 E. cloacae, and 1 K. aerogenes); and 7 with ESBL and AmpC (6 E. cloacae and 1 K. pneumoniae).
Isolates were identified using the MicroScan system (Beckman Coulter, Brea, CA, USA) and mass spectrometry (Maldi-Tof®, Bruker Daltonik GmbH, Bremen, Germany). Resistances were characterized with the MicroScan microdilution system, followed, when appropriate, by carbapenemase determination using the Rapidec® Carba NP colorimetric test (BioMerieux, Marcy l’Etoile, France) and immunochromatography (NG5-Test Carba, NG Biotech, Guipry, France). The carbapenemase-producing type was confirmed by the Andalusian Molecular Typing Laboratory of the Spanish PIRASOA Program using mass sequencing (Illumina Inc, San Diego, CA, USA), CLC Genomics Workbench v10 software (Qiagen), ResFinder (Lyngby, Denmark) (https://cge.cbs.dtu.dk/services/ResFinder, (accessed on 30 November 2021)), and CARD (Hamilton, ON, Canada) (https://card.mcmaster.ca/, (accessed on 30 November 2021)) databases. ESBL production was defined by resistance to cefotaxime (CTX) and/or ceftazidime (CAZ) and synergy with clavulanic acid (CLAV) and FEP, and by susceptibility to amoxicillin/CLAV, piperacillin/tazobactam, FOX, and carbapenems. AmpC production was defined by synergy with cloxacillin [3] (with gradient test, cefotetan/cefotetan-CLX E-Test (CTT/CXT), Liofilchem®—MIC Test Strip Technical Sheet AmpC), resistance to FOX, amoxicillin/clavulanic acid/CLAV, piperacillin/tazobactam, and CTX and/or CAZ, with an increased minimal inhibitory concentration (MIC) in the presence of CLAV and susceptibility to FEP and carbapenems.
A 0.5 McFarland suspension of each isolate was prepared from colonies grown on lamb blood agar (Becton Dickinson, Franklin Lakes, NJ, USA). Next, a sterilized swab was soaked with the homogenized suspension, excess liquid was removed, and it was uniformly seeded on one half of the plate on CHROMID ESBL medium, streaking the bacterial load on the other half with a calibrated inoculation loop. FEP (30 µg, Becton Dickinson), FOX (30 µg, Becton Dickinson), ETP (10 µg, Becton Dickinson), and CLX (in two variants [test 1 and test 2] to detect AmpC) disks were then placed equidistantly on the seeded area for growth/inhibition measurement with a separation of 1.5 cm between each. The medium was then incubated at 37 °C, with readings at 24 h. Test 1 used a sterile paper disk (BBL TM TAXO TM Blank Paper Disks, Becton Dickinson) with a diameter of 13 mm located at the center of the plate with the addition of 20 µL CLX (50 mg/mL) (Sigma-Aldrich, Madrid, Spain); and Test 2 used a disk with 1 µg oxacillin (Becton-Dickinson) with addition of 10 µL CLX (50 mg/mL). IBM SPSS Statistics 19 and Microsoft Excel 2019 were used for statistical analyses. Calculations were made of the diagnostic value of the presence of synergy when applying Tests 1 and 2.
3. Results
3.1. Systematic Review
3.1.1. Worldwide AmpC-BL Epidemiology
Three AmpC-BL categories have been described: chromosomal type AmpC-BL with inducible expression; chromosomal type AmpC-BL with stable derepression and non-inducible expression (enzyme hyperproduction by mutations in AmpC regulating genes); and plasmid type AmpC-BL (encoded by genes in transfer plasmids) (12). The former enzymes are expressed constitutively and at low concentrations in Citrobacter spp., Enterobacter spp., Serratia spp., Morganella spp., and Providencia spp. (CESPM group), and in Pseudomonas aeruginosa [5,12,13]. However, exposure of these bacterial species to certain beta-lactams can lead to hyperexpression of the encoding gene and elevated production of cAmpC-BL, with the expression of AmpC-BL being inducible. This is attributed to mutations that affect the enzyme responsible for regulating the AmpC-BL gene [3]. Its constitutive expression at low concentrations has also been documented in other bacteria, such as E. coli, and in Shigella spp., but it is not inducible in these cases because the chromosomal genes of the enzyme lack the natural promoter (ampR). Nonetheless, Pfeifer et al. (2010) described cases of resistance to cephalosporins in E. coli mediated by the inducible expression of cAmpC-BL, caused by mutations that increased expression of the enzyme [14]. The rise in plasmid type AmpC-BL over the past few years has been described as an epidemic by some authors [12]. In 1989, it was discovered that ampC genes may be transmittable by plasmids [4,15], after the finding in South Korea of an isolate highly resistant to FOX, designated plasmid CMY-1 [15]. pAmpC-BLs have traditionally been described in Enterobacteriaceae and other Gram-negative bacilli [3,5] (Table 1). The various plasmid AmpC families have been grouped as follows: CIT group of C. freundii (including LAT- and some CMY-, such as CMY-2 and BIL); EBC group of Enterobacter spp. (MIR-1, ACT-1); DHA group of M. morganii (DHA-1, DHA-2); ACC group of H. alvei (highlighting ACC-1); MOX group of Aeromonas spp. (MOX- and the rest of CMY); and FOX group, observing a very close genetic relationship between these plasmids and their chromosomal origins [4,16].

Table 1.
Isolation of the first pAmpC-BLs (modified by Jacoby, 2009) [3].
Species that can express pAmpC-BL include K. pneumoniae, Salmonella, E. coli, P. mirabilis, and C. freundii, in which these genes are constitutively expressed at high concentrations [15]. All pAmpC-BLs are expressed constitutively, except for DHA-1, ACT-1, DHA-2, and CMY-13 enzymes. These have been described as inducible because the plasmids that contain them include not only the encoding ampC genes for the enzyme but also ligated ampR genes. These genes are transcription factors responsible for decreasing or increasing the expression of inducible ampC genes depending on the cofactor that interacts with AmpR [3,5,13,15,17,18]. Since the discovery of this type of plasmid, it has been repeatedly observed that the most frequently recorded ampC gene worldwide is CMY-2 [7,14,17,18,19,20], followed by DHA-1 [18]. Enzymes in the CIT group (CMY-like) are predominant in E. coli, while enzymes of the DHA family predominate in Klebsiella spp. [19,20,21,22,23].
As in the case of Gram-negative bacteria families, AmpC-BL-producing microorganisms produce various types of infection, both nosocomial and community-acquired: urinary tract infections (UTIs, E. coli being the most frequently isolated pathogen in this type of infection), intra-abdominal infections, pneumonias, and soft tissue infections, among others [23]. The literature describes various risk factors associated with infections by pAmpC-BL-carrier microorganisms, observing that they do not differ from those described for ESBLs [24], associating AmpC-BL acquisition with previous hospitalization even more than ESBL acquisition [25].
Independent risk factors have been reported for infection by pAmpC-BL-producing microorganisms, including the previous receipt of fluoroquinolones [2,26,27] and cephalosporins such as cephamycin and FOX [2,3,26,27,28], demonstrating the possible therapeutic failure of using cephalosporins as empirical treatment (30) even being considered as an independent risk factor [2,25]. In addition, not all AmpC plasmid families are associated with the same mortality rate; thus, according to the report of Pai et al. (2004), infections produced by AmpC-BL DHA-1 have a higher mortality rate than those produced by CMY-2 [29]. Other risk factors are prolonged hospitalization [2,3,4,28,30] or patient institutionalization (in the study by Rodríguez-Baño et al. (2015)) [25], more than 50% of infections were associated with community outbreaks, especially in patients with associated health care), hospitalization in intensive care units (ICUs), and use of central and urinary catheters [3,25,28], mainly in the case of nosocomial infections. Age, presence of diabetes mellitus, hospital admission, institutionalization in care homes, and the use of urinary catheters were associated with community-acquired infections [2].
The worldwide epidemiology of pAmpC-BLs was evaluated by classifying studies according to their target population in the following three groups: hospital (isolates of patients admitted to hospital centers, including ICUs and health institutions), community (isolates from community sampling, studies performed in primary care, infections acquired in the community, and non-hospitalized patients), and hospital and community. The prevalence of AmpC in the reviewed literature was evaluated by considering the total number of isolates in each study. Table 2, Table 3, Table 4 and Table 5 display data were obtained from Europe, America, Africa, and countries in Asia, Oceania, and the Middle East, respectively.
PRESENCE IN EUROPE (Table 2). Major regional differences can be observed in the percentage of pAmpC-BL positivity. It has remained relatively low in Europe over the past 10 years, ranging from 0.06% Denmark (2010) [31] to 2.6% in Holland (2014) [30,32]. However, higher percentages of positivity have occasionally been observed, such as Holland in 2012 with 5% [33], Spain in 2018 with 14.2% [34], and Germany in 2020 with 11.9% positivity. These higher positivity rates may result from differences in screening method or study population (36). For instance, resistance of clinical isolates to carbapenems was used in the 2018 Spanish study [34] while the 2012 study in Holland evaluated isolates with reduced susceptibility to FOX [33]. pAmpC-BL positivity in E. coli is generally less frequent in Europe than that observed in other parts of the world, with percentages of 0.06% reported in Denmark (2010) [31], 0.46% in France (2010) [35], 0.73% in Holland and Germany (2017) [36], 1.28% in Portugal (2019) [37], and 2.4% in Holland (2018) [38]. The prevalence was slightly higher (7.55%) in the study by Findlay et al. (2020) in England, because all of the clinical isolates evaluated showed CTX resistance, used as a screening method [39]. An elevated prevalence of pAmpC-BL was also obtained in Ireland (19%) because the isolates had a AmpC phenotype (positivity in the phenotypic detection procedure) [40]. In the same way, the elevated percentage (12.5%) described in Switzerland (2013) [41] was obtained in isolates with resistance to third-generation cephalosporins. Reports on the positivity of K. pneumoniae isolates have varied among European countries, with findings of 0.5% in France (2012) [42], 0.47% in Holland (2012) [33], and 1.04% in Portugal (2019) [37].

Table 2.
Epidemiology of pAmpC-BLs in Europe (2010–2020).
Table 2.
Epidemiology of pAmpC-BLs in Europe (2010–2020).
| Author (Reference) | Year of Population Study | Year of Publication | Country of Target Population | Population (H/C) a | Specific Conditions | n | AmpC (%) b | Global c | Genetic Identification | Most Frequent AmpC Enzymes | |
|---|---|---|---|---|---|---|---|---|---|---|---|
| E. coli | K.pneumoniae | ||||||||||
| Jørgensen et al. [31] | 2006 | 2010 | Denmark | H | ECI | 74 | 0.06 | - | - | PCR/WGS | CMY-2 |
| Courpon-Claudinon et al. [35] | 2005 | 2010 | France | H | 3GCR | 1051 | 0.46 | - | - | PCR/WGS | CMY-2 |
| Illiaquer et al. [42] | 2007–2009 | 2012 | France | H | KPI | 1505 | - | 0.50 | - | PCR/WGS | DHA-1 |
| Voets et al. [33] | 2009 | 2012 | Holland | C | ESBL | 636 | 3.93 | 0.47 | 5.03 | PCR/WGS | CMY-2 |
| Miró et al. [43] | 2009 | 2013 | Spain | H | EI | 100,132 | 0.69 | 1.02 | 0.64 | PCR/WGS | CMY-2 |
| Seiffert et al. [41] | 2011 | 2013 | Switzerland | H/C | ECI | 611 | 12.50 | - | - | PCR/WGS | CMY-2 |
| Gude et al. [44] | 2008–2010 | 2013 | Spain | H | EI | - | - | - | 0.56 | PCR/WGS | CMY-2 |
| Galán-Sánchez et al. [45] | 2011–2012 | 2014 | Spain | H/C | ECI | - | 0.78 | - | - | PCR/WGS | CMY-2 |
| Reuland et al. [30] | 2007 | 2014 | Holland | H | 3GCR | 503 | - | - | 2.60 | PCR | CMY-2 |
| Jones-Dias et al. [46] | 2004–2008 | 2014 | Portugal | H | 3GCR | 124 | - | - | 0.80 | PCR/WGS | CMY-2 |
| Reuland et al. [47] | 2011 | 2015 | Holland | C | EI | 550 | 1.30 | - | - | PCR | CMY-2 |
| Ibrahimagić et al. [48] | 2009–2010 | 2015 | Bosnia and Herzegovina | H/C | ESBL | 85 | - | - | 8.23 | PCR | CMY-2 |
| Alonso et al. [49] | 2010–2011 | 2016 | Spain | H/C | ECI | 21,563 | 1.10 | - | - | PCR/WGS | CMY-2 |
| Li et al. [40] | 2011–2012 | 2015 | Ireland | H | 3GCR | 95 | 19 | - | - | PCR/WGS | CIT group |
| Pascual et al. [50] | 2010–2011 | 2016 | Spain | H/C | 3GCR | 841 | 2.02 | - | - | PCR/WGS | CMY-2 |
| Zhou et al. [36] | 2012–2013 | 2017 | Holland/Germany | H/C | EI | 1087 | 0.73 | - | - | PCR/WGS | CMY-2 |
| Gómara et al. [34] | 2013–2014 | 2018 | Spain | H | CR | 63 | - | - | 14.2 | PCR | CIT group |
| Den Drijver et al. [38] | 2013–2016 | 2018 | Holland | H | EI | 2126 | 2.40 | - | - | PCR | CMY-2 |
| Ribeiro et al. [37] | 2010–2016 | 2019 | Portugal | H | 3GCR | 1246 | 1.28 | 1.04 | 2.60 | PCR/WGS | DHA-1 |
| Findlay et al. [39] | 2017–2018 | 2020 | England | C | 3GCR | 225 | 7.55 | - | - | PCR/WGS | DHA-1 |
| Rohde et al. [51] | 2014–2015 | 2020 | Germany | C | 3GCR | 828 | - | - | 11.90 | PCR/WGS | CMY-2 |
a Type of population studied: Hospital (H)/Community (C). b Percentage positivity for AmpC among all isolates evaluated in the study. c Percentage global positivity that includes species other than E. coli and K. pneumoniae and/or does not differentiate between cAmpC-BL and pAmpC-BL. PCR: polymerase chain reaction; WGS: whole genome sequencing; ECI: E. coli isolates; 3GCR: third-generation cephalosporin-resistant; EI: Enterobacteriaceae isolates; KPI: K. pneumoniae isolates; ESBL: extended spectrum beta-lactamase; CR: carbapenemase resistant.
PRESENCE IN AMERICA (Table 3). Our search of the literature retrieved few publications on the prevalence of pAmpC-BL in America. In general, the global prevalence of pAmpC-BL has been relatively low in the USA, ranging between 1.3% in 2016 [32] and 3.42% in 2019 [52]. Reports on the prevalence of pAmpC-BL in E. coli have ranged widely between 2.23%, as described by Tamma et al. (2019) [52], and 16.33%, reported by Park et al. (2012), who studied the presence of pAmpC-BL in FOX-resistant isolates [53]. In Mexico, Paniagua-Contreras et al. (2018) found a higher prevalence (23.7%) of AmpC-BL among E. coli isolates [54].

Table 3.
Epidemiology of pAmpC-BLs in America (2010–2020).
Table 3.
Epidemiology of pAmpC-BLs in America (2010–2020).
| Author (Reference) | Year of Population Study | Year of Publication | Country of Target Population | Population (H/C) a | Specific Conditions | n | AmpC (%) b | Global c | Genetic Identification | Most Frequent AmpC Enzymes | |
|---|---|---|---|---|---|---|---|---|---|---|---|
| E. coli | K.pneumoniae | ||||||||||
| Park et al. [53] | 2008–2012 | 2012 | USA | H | 3GCR | 300 | 16.33 | - | - | PCR/WGS | CMY-2 |
| Suwantarat et al. [32] | 2014–2015 | 2016 | USA | H | EI | 854 | - | - | 1.30 | PCR/WGS | CMY-2 |
| Logan et al. [55] | 2011–2015 | 2016 | USA | H | MDR | 225 | 14.22 | - | - | PCR/WGS | CMY-2 |
| Paniagua-Contreras et al. [54] | Data not available | 2018 | Mexico | C | ECI | 194 | 23.70 | - | - | PCR | CIT group |
| Tamma et al. [52] | 2014–2015 | 2019 | USA | H | EI | 1,929 | 2.23 | 0.88 | 3.42 | PCR | CMY-2 |
a Type of population studied: Hospital (H)/Community (C). b Percentage of positivity for AmpC among all isolates evaluated in the study. c Percentage global positivity that includes species other than E. coli and K. pneumoniae and/or does not differentiate between cAmpC-BL and pAmpC-BL. PCR: polymerase chain reaction; WGS: whole genome sequencing; ECI: E. coli isolates; 3GCR: third-generation cephalosporin-resistant; EI: Enterobacteriaceae isolates; MDR: multidrug resistant.
PRESENCE IN AFRICA (Table 4). Reports on the prevalence of pAmpC-BL have varied widely among African countries. E. coli percentages have ranged from 0.50 in Tanzania (2016) [56] and 0.59% in Morocco (2013) [57] to 14.68% in Egypt (2014) [58], with reports of 4.23% in Nigeria (2014) [59] and 10.86% in Mozambique (2021) [60]. Likewise, the percentages of K. pneumoniae isolates have ranged between 0.88 in Morocco (2013) [57] and 3.97% in Libya (2017) [61]. Overall, the highest prevalence rates of pAmpC-BL have been described in Uganda (2014) [60], with a rate of 39.6% among FOX-resistant isolates; in Egypt (2014) with 18.8% [58]; and in Nigeria (2014) with 11.23% [59].

Table 4.
Epidemiology of pAmpC-BLs in Africa (2010–2020).
Table 4.
Epidemiology of pAmpC-BLs in Africa (2010–2020).
| Author (Reference) | Year of Population Study | Year of Publication | Country of Target Population | Population (H/C) a | Specific Conditions | n | AmpC (%) b | Global c | Genetic Identification | Most Frequent AmpC Enzymes | |
|---|---|---|---|---|---|---|---|---|---|---|---|
| E. coli | K. pneumoniae | ||||||||||
| Ogbolu et al. [62] | 2005–2007 | 2011 | Nigeria | H | EI | 134 | - | - | 4.50 | PCR/WGS | DHA-1 |
| Barguigua et al. [63] | 2010 | 2013 | Morocco | C | ECI | 1,174 | 0.59 | - | - | PCR/WGS | CIT group |
| Barguigua et al. [57] | 2010–2011 | 2013 | Morocco | C | KPI | 453 | - | 0.88 | - | PCR/WGS | EBC group |
| Yusuf et al. [59] | Data not available | 2014 | Nigeria | H/C | EI | 543 | 4.23 | 3.50 | 11.23 | - | - |
| Helmy et al. [58] | 2011–2012 | 2014 | Egypt | H | EI | 143 | 14.68 | 2.09 | 18.18 | CIT group | |
| Nakaye et al. [64] | 2013 | 2014 | Uganda | H | 3GCR | 293 | - | - | 39.60 | PCR | EBC group |
| Gharout-Said et al. [65] | 2005–2010 | 2015 | Algeria | H | EI | 922 | - | - | 1.60 | PCR/WGS | CMY-4 |
| Chérif et al. [66] | 2006–2009 | 2015 | Tunisia | H | EI | 11,393 | - | - | 0.59 | PCR/WGS | CMY-2 |
| Tellevik et al. [56] | 2010–2011 | 2016 | Tanzania | H/C | EI | 603 | 0.50 | - | - | PCR/WGS | CMY-2 |
| Zorgani et al. [61] | 2013–2014 | 2017 | Libya | H | EI | 151 | 1.98 | 3.97 | 5.96 | PCR | CIT group |
| Tanfous et al. [67] | 2002–2011 | 2018 | Tunisia | H | KPI | 128 | - | 2.30 | - | PCR/WGS | CMY-4 |
| Tanfous et al. [68] | 2002–2013 | 2018 | Tunisia | H | ESBL | 128 | - | 2.34 | - | PCR/WGS | CMY-4 |
| Rensing et al. [69] | 2013 | 2019 | Egypt | H/C | EI | 225 | 1.45 | 0.97 | 2.91 | PCR | CIT group |
| Mohamed et al. [70] | 2018 | 2020 | Egypt | C | EI | 440 | 2.04 | 2.04 | 4.09 | PCR/WGS | DHA-1 |
| Estaleva et al. [60] | 2015 | 2021 | Mozambique | H/C | ECI | 230 | 10.86 | - | - | PCR/WGS | FOX/MOX |
a Type of population studied: Hospital (H)/Community (C). b Percentage positivity for AmpC among all isolates evaluated in the study. c Percentage global positivity that includes species other than E. coli and K. pneumoniae and/or does not differentiate between cAmpC-BL and pAmpC-BL. PCR: polymerase chain reaction; WGS: whole genome sequencing; ECI: E. coli isolates; 3GCR: third-generation cephalosporin-resistant; EI: Enterobacteriaceae isolates; KPI: K. pneumoniae isolates; ESBL: extended spectrum beta-lactamase.
PRESENCE IN ASIA, OCEANIA, AND THE MIDDLE EAST (Table 5). These regions have reported the highest prevalence rates of pAmpC-BL isolation. The rate of K. pneumoniae ranges from 0.01% in Japan (2010) [21] to a very high rate of 44.95% in a Hong Kong study (2016) [71]. Elevated rates have also been described in India (2010 and 2012) [72,73] with 13.14% and 13.27% positivity, respectively; Pakistan (2013) [74], with 12.37% positivity among isolates with ESBL phenotype; and China (2015) [75], with 31.50% positivity among multi-drug resistant K. pneumoniae isolates. Positivity rates in E. coli have ranged from 0.07% in Japan (2010) [21] to India (2010 and 2012) [72,73] with 24.57% and 24.89% positivity, respectively.

Table 5.
Epidemiology of pAmpC-BLs in Asia, Oceania, and the Middle East (2010–2020).
Table 5.
Epidemiology of pAmpC-BLs in Asia, Oceania, and the Middle East (2010–2020).
| Author (Reference) | Year of Population Study | Year of Publication | Country of Target Population | Population (H/C) a | Specific Conditions | n | AmpC (%) b | Global c | Genetic Identification PCR/WGS | Most Frequent AmpC Enzymes | |
|---|---|---|---|---|---|---|---|---|---|---|---|
| E. coli | K. pneumoniae | ||||||||||
| Yoo et al. [76] | 2008–2009 | 2010 | South Korea | H | EI | 276 | 1,81 | 16.66 | - | PCR | DHA-1 |
| Yamasaki et al. [21] | 2002–2008 | 2010 | Japan | H/C | EI | 22,869 | 0.07 | 0.01 | 0.13 | PCR/WGS | CMY-2 |
| Singtohin et al. [77] | 2005–2006 | 2010 | Thailand | H | EI | 2,712 | 1.62 | 0.29 | 1.91 | PCR | CMY-2 |
| Mohamudha et al. [72] | 2008 | 2010 | India | H | EI | 175 | 24.57 | 13.14 | 44.57 | - | - |
| Mohamudha et al. [73] | 2009–2010 | 2012 | India | H | EI | 241 | 24.89 | 13.27 | 38.17 | PCR | DHA-1 |
| Manoharan et al. [78] | 2007–2008 | 2012 | India | H | 3GCR | 312 | - | - | 15.38 | PCR | CIT group |
| Matsumura et al. [79] | 2010 | 2012 | Japan | H | ECI | 1,327 | 1.73 | - | - | PCR/WGS | CMY-2 |
| Gupta et al. [80] | 2008–2009 | 2012 | India | H | KPI | 100 | - | 32 | - | PCR | CMY-2 |
| Sasirekha et al. [81] | 2008 | 2012 | India | H | EI | 90 | 4.44 | 3.33 | 7.77 | - | - |
| Shafiq et al. [82] | 2008 | 2013 | Pakistan | H/C | ESBL | 511 | 7.97 | 12.37 | - | - | - |
| Azimi et al. [83] | 2013 | 2015 | Iran | H | KPI | 303 | - | 1.60 | - | PCR/WGS | CMY- |
| Hou et al. [75] | 2011 | 2015 | China | H | KPI- MDR | - | 31.50 | - | PCR | DHA- | |
| Liu et al. [84] | 2012 | 2016 | China | H | ECI | 96 | 12.50 | - | - | PCR | DHA-1 |
| Liu et al. [85] | 2012 | 2016 | China | H | KPI | 130 | - | 10.80 | - | PCR/WGS | DHA-1 |
| Ghosh et al. [86] | Data not available | 2016 | India | H | EI | 148 | 16.89 | - | - | PCR/WGS | CMY-2 |
| Luk et al. [71] | 2004–2008 | 2016 | Hong Kong | H | KPI | 109 | - | 44.95 | - | PCR | DHA-1 |
| Sadeghi et al. [87] | 2014 | 2016 | Iran | H | EI | 307 | - | - | 21.50 | PCR/WGS | CMY-2 |
| Baljin et al. [88] | 2014 | 2016 | Mongolia | H | EI | 478 | 0.41 | - | - | PCR/WGS | CMY-2 |
| Noguchi et al. [89] | 2011–2012 | 2017 | Japan | H | EI | 316 | 0.63 | 0.95 | - | PCR/WGS | DHA-1 |
| Khurana et al. [29] | 2013–2015 | 2017 | India | H | GNB | 761 | 0.52 | - | - | PCR | FOX-1/FOX-5b |
| Abdalhamid et al. [90] | 2015 | 2017 | Saudi Arabia | H | EI | 3,625 | - | - | 1 | PCR/WGS | CMY-2 |
| Harris et al. [22] | 2014–2015 | 2018 | Australia, New Zealand, Singapore | H | 3GCR | 30 | 17.10 | - | - | PCR/WGS | CMY-2 |
| Nishimura et al. [91] | 2005–2011 | 2018 | Japan | H | EI | 8,299 | 0.54 | - | 1.75 | PCR/WGS | CIT group |
| Kim et al. [92] | 2007–2016 | 2019 | South Korea | H | ECI | 1,047 | 1.52 | - | - | PCR/WGS | DHA-1 |
| Rizi et al. [93] | 2018 | 2020 | Iran | H | EI | 602 | - | - | 9.30 | PCR | CMY-2 |
| Shrestha et al. [94] | 2013–2014 | 2020 | Nepal | H/C | ECI | 2,661 | 9.86 | - | - | - | - |
| Aryal et al. [95] | 2017–2018 | 2020 | Nepal | H | GNB | 226 | - | - | 40.26 | PCR | CIT group |
| Bala et al. [96] | 2018 | 2020 | India | H | ECI | 470 | 11.10 | - | - | PCR | CIT group |
a Type of population studied: Hospital (H)/Community (C). b Percentage positivity for AmpC among all isolates evaluated in the study. c Percentage global positivity that includes species other than E. coli and K. pneumoniae and/or does not differentiate between cAmpC-BL and pAmpC-BL. PCR: polymerase chain reaction; WGS: whole genome sequencing; ECI: E. coli isolates; 3GCR: third-generation cephalosporin-resistant; EI: Enterobacteriaceae isolates; KPI: K. pneumoniae isolates; ESBL: extended spectrum beta-lactamase; GNB: Gram-negative bacilli; MDR: multidrug resistant.
3.1.2. Phenotypic Detection Methods
Since the discovery of AmpC type resistances several decades ago, the approach to their detection has been controversial, attributable to the lack of clear guidelines from CLSI or EUCAST. This has led to an underdiagnosis of AmpC-BLs, contributing to underestimation of the prevalence and global spread of this type of resistance. In 2018, Conejo et al. (2018) called for an improvement in the phenotypic detection of AmpC-BLs in Spanish clinical laboratories [97]. The ability of a laboratory to detect both types of AmpC resistance is essential, and the detection of pAmpC-BLs is of vital epidemiological importance, given their transmission and dissemination capacity and their association with outbreaks of community and nosocomial infections [17,98]. AmpC-BL detection is especially difficult in microorganisms that can produce chromosomal and plasmid AmpC-BL (e.g., E. coli). In these cases, the presence of a plasmid needs to be investigated to monitor their spread more closely [99] and address the clinical, therapeutic, epidemiological, and organizational repercussions, including the isolation of infected patients. For the laboratory detection of these resistances, the presence of pAmpC-BLs should be surveilled in species without chromosomal AmpCs that have proven able to disseminate these enzymes, mainly K. pneumonia [100]. The behavior of antibiotics against pAmpC-BL-producing microorganisms is characterized by a decreased susceptibility to oxyimino-cephalosporins (e.g., CTX or CAZ) and methoxy-cephalosporins (e.g., FOX), and a susceptibility to fourth-generation cephalosporins (e.g., FEP) [17,101]. Therefore, isolates showing some of these characteristics in the antibiogram should be suspected of pAmpC-BL production when there is no other apparent cause. However, there have been multiple reports of AmpC-producing bacteria that appeared susceptible to both oxyimino-cephalosporins and FOX in the antibiogram [18,19,24,97,99,102,103,104,105,106]. This may be attributable to a so-called “inoculum effect” (susceptibility in vitro at low microorganism concentrations but inefficacy in vivo) [24,106] or to the conventional consideration of these isolates as susceptible to cephalosporins in vitro according to now-outdated CLSI or EUCAST cutoff points [103,106]. It should be borne in mind that pAmpC-BL-producing isolates occasionally present with more than one beta-lactamase and are multidrug resistant [4,75,94,101]. The presence of AmpC can mask the coexistence of ESBL, hampering differentiation of the two resistances [22,79,99,105,107,108], because the two enzyme groups are hydrolytically very similar, except that AmpC-BL is not inhibited by CLAV, with reports of an increased cephalosporin MIC in its presence [107].
There appears to be a consensus that AmpC-BL screening should consider reduced susceptibility to cephamycins and/or oxyimino-cephalosporins, specifically FOX resistance, alongside the occasional resistance to conventional inhibitors such as CLAV. However, CLAV resistance should be evaluated with caution, given that some isolates may appear susceptible [4]. Accordingly, Meini et al. (2019) proposed routine laboratory FOX screening in laboratories for the detection of AmpC-BLs, proposing FOX MIC > 8 mg/L combined with resistance to CTX and/or CAZ as phenotypic indicator of the presence of pAmpC-BL [17,30]. EUCAST recommends investigating the presence of AmpC when the aforementioned antibiogram results are obtained [98]. Other authors have also recommended screening for susceptibility to FEP, to which AmpC-BLs are susceptible [109]. However, it should be borne in mind that some E. coli isolates can have reduced susceptibility to FEP (MICs ranging from 0.5 to 12 μg/mL), being known as E. coli producing extended-spectrum AmpC (ESAC) beta-lactamases [110]. Other drawbacks of phenotypic tests are their incapacity to differentiate pAmpC-BL producers if they present inducible cAmpC-BL. Known limitations of phenotypic tests also include confluence with other resistance mechanisms such as ESBLs and porin loss [111]. Specific phenotypic tests are based on the detection of AmpC enzyme hydrolytic activity or utilization of AmpC inhibitors and their capacity to suppress beta-lactamase expression [112]. Various phenotypic methods have been proposed for detecting AmpC-producing microorganisms:
- -
- Disk approximation method. This technique is employed to detect inducible AmpC-BLs. In the case of pAmpC-BLs, it would be valid for the AmpCs of DHA-1, DHA-2, ACT-1, and CMY-13 families. Two disks are used, one with a substrate antibiotic such as an oxyimino-cephalosporin (e.g., CAZ) or piperacillin/tazobactam, and the other with an inducer antibiotic (e.g., FOX, CLAV, or imipenem, etc.). The microorganism produces an inducible BL if the substrate antibiotic inhibition halo is reduced in the area close to FOX [113].
- -
- Methods with AmpC-specific inhibitors. CLX and boronic acid (BA), and their derivatives, have proven to be the most active and effective commercially available inhibitors to detect AmpC-BLs [105,113,114,115], with CLX being more specific [114,116]. The combination of CTT with other inhibitors, such as Ro48-1220 and LN-2-128 [117,118] or Syn2190 [101,118], especially Syn2190, have demonstrated high sensitivity and specificity to detect AmpC-producing microorganisms; however, they are not commercially available. The main methods include:
- (a)
- Double-disk potentiation methodwith BA or CLX [98,113,119,120,121]. Cephalosporin disks, especially CTT, FOX, CAZ, or CTX, are used alone and supplemented with BA or CLX, obtaining a positive result when the difference in inhibition halo in the disk with inhibitor is >5 mm.
- (b)
- Double-disk synergy method with double BA [113,115,120] or CLX [3,28,120]. A BA or CLX disk is placed with a CAZ disk and CTX disk on both sides. The test is positive when the inhibition halo is distorted (augmented).
- (c)
- AmpC detection disks. This technique, described by Black et al. (2005) [122], uses Tris-EDTA to permeabilize the bacterial membrane and release beta-lactamases. The bacterium suspected of producing pAmpC-BL (study bacterium) is added to the AmpC disks, which contain Tris-EDTA. The medium is inoculated with an isolate known to be susceptible to FOX (control bacterium), and a FOX disk with AmpC disks (containing the studied bacterium) is placed on both sides. A flattening of the FOX inhibition halo indicates antibiotic inactivation (i.e., the presence of AmpC enzyme released into the medium from the studied bacterium) and therefore a positive result for the presence of pAmpC-BL [28,113,122].
- (d)
- Three-dimensional method. A FOX disk is placed in an agar plate inoculated with a strain susceptible to this antibiotic. An incision is made in the agar near the disk for inoculation with the microorganism under study. The result is positive when the inhibition halo is flattened, which is caused by the growth of the AmpC-producing microorganism [73,113,121].
- (e)
- Mast disks (MastDics® Combi AmpC and ESBL Detection Set, Merseyside, UK) (Figure 1A–D) [123]. This technique, which can be used to detect both AmpC and ESBL, utilizes cefpodoxime disks, alone and combined with AmpC inhibitor and/or ESBL inhibitor. The result is positive when the difference in halo diameter between disks with versus without inhibitor is >5 mm [112].
- (f)
- E-test® AmpC (Biomérieux SA, 69280, Marcy-l´Etoile, France) (Figure 1E) [124]. This test utilizes strips impregnated with CTT at increasing concentrations on both sides, with the presence of CLX on only one side. The result is positive if there is a CTT MIC reduction of at least three dilutions or deformation of the ellipse in the presence of CLX [52,112,121].
- (g)
- ESBL + AmpC Screen ID Kit (ROSCO, Albertslund, Denmark). Similar concept to the Mast disks referred to in point e). In this case, the cephalosporin is cefotaxime [125,126].
Figure 1.
Phenotypic methods of AMPc beta-lactamase detection (Available online: https://mast-group.com/uk/products/amr/antibiotic-resistance-detection-sets/d68c/ (accessed on 25 October 2021)). Mast Disk test, with four disks [123]: Disk A(Cefpodoxime), disk B (Cefpodoxime + ESBL inhibitor), disk C (Cefpodoxime + AmpC inhibitor), disk D (Cefpodoxime + AmpC inhibitor + ESBL inhibitor). (A): positive result for AmpC production alongside ESBL production; (B): positive result for AmpC production; (C): positive result for ESBL production; (D): no AmpC or ESBL production. Image (E) depicts the AmpC E-test with cefotetan (CN) and cefotetan with cloxacillin (CNI), showing a positive result for the presence of AmpC beta-lactamase with a major reduction in MIC at the CNI end [124].
3.1.3. Genotypic Detection Methods
Multiplex PCR has been considered the gold standard technique for the detection of pAmpC-BL since its development by Pérez-Pérez et al. in 2002. It permits the detection and differentiation of plasmid AmpC families and of their chromosomal or plasmid origin (valuable for species with both types of AmpC, such as E. coli) [16]. Modifications have been introduced since its invention, including simple PCRs that offer the same diagnostic value and may even be used for screening (Dallenne et al., 2009] [127]; real-time PCR (Brolund et al., 2010) [128] for rapid detection, using affordable reagents; and, more recently, multiplex real-time PCR (Chavda et al., 2016) [129], which offers the identification of AmpC along with other types of resistance, again in a relatively short time. Voets et al. (2011) [130] developed a novel multiplex PCR capable of identifying up to 25 types of beta-lactamases in one amplification reaction (including ESBL, pAmpC, carbapenemases, etc.), and Geyer et al. (2012) [131] obtained 100% sensitivity and specificity using multiplex real-time PCR. Liu et al. (2015) [132] created a rapid and more cost-effective technique that allowed 96 samples to be tested within 2 h using standard real-time PCR equipment.
It was initially considered impossible for a single isolate to express more than one pAmpC-BL for two reasons: AmpC detection is not sufficiently precise, and the amount of AmpC in the bacterium is too limited for it to be a viable pathogen [16,132]. However, it is now considered possible, given that various authors have reported the finding of more than one ampC gene in the same isolate [45,52,61,66,93].
3.1.4. Behavior of Enterobacteriaceae with AmpC-BL in ChromID® ESBL Medium, Using Disk Diffusion Test with CLX Disks
The behaviors of test 1 (Figure 2A) and test 2 (Figure 2B) are exhibited in Table 6, Table 7 and Table 8.

Figure 2.
Screening method for the phenotypic detection of AmpC. (A): Image of test 1, depicting the synergy between the large white disk with CLX (20 µL at concentration of 50 mg/mL) and ETP and FEP susceptibility halos. (B): Image of test 2, depicting the same synergy phenomenon as in A, but in this case between the oxacillin disk with CLX (10 µL at concentration of 50 mg/mL) and ETP and FEP disks. CLX (cloxacillin); ETP (ertapenem); FEP (cefepime); FOX (cefoxitin).

Table 6.
Detection of isolates with AmpC using test 1.

Table 7.
Detection of isolates with AmpC using Test 2.

Table 8.
Usefulness of screening methods with tests 1 and 2.
Screening test 1 (Figure 2A) to detect AmpC producers, either as sole resistance mechanism or in combination with ESLB production, had a sensitivity of 31.3%, specificity of 100%, positive predictive value of 100%, and negative predictive value of 88.7%. When the test was applied to detect AmpC producers alone (not combined with ESBL), the sensitivity was 55.6%, the specificity 100%, positive predictive value 100%, and negative predictive value 95.6%.
Screening test 2 (Figure 2B) to detect AmpC producers, either as a sole resistance mechanism or in combination with ESLB production, had a sensitivity of 62.5%, specificity of 100%, positive predictive value of 100%, and negative predictive value of 93.5%. When the test was applied to detect AmpC producers alone (not combined with ESBL), the sensitivity was 88.9%, specificity 100%, positive predictive value 100%, and negative predictive value 98.9%.
Comparison of test results using the Youden index showed that test 2 had greater predictive capacity. Notably, a Youden index of 0.889 was obtained for the detection of AmpC-producing isolates without the presence of ESLB producers.
4. Discussion
This review reveals increasing research interest in pAmpC-BLs over the past few years. Numerous scientific publications have described their detection in the environment, including aquatic media, in food production, and in samples from animals and humans [133].
The reviewed data show that the overall prevalence of pAmpC-BL is higher in the region comprising Asia, Oceania, and the Middle East than in the rest of the world, especially India (44.47% in 2012) [72], Nepal (40.26% in 2020) [95], and Iran (20.50% in 2020) [87]. The lowest prevalence has been reported in Europe, followed by America. Nevertheless, it should be taken into account that some studies did not differentiate between cAmpC-BL and pAmpC-BL, and may therefore have overestimated the prevalence of pAmpC-BL. Prevalence data also vary markedly according to the methodology applied, which may at least in part explain the wide differences reported among countries [51,61,72,86,91,93] and among regions, bacterial species, and study dates [121]. For example, the percentage of pAmpC-BL positivity described by Shrestha et al. (2020) in Nepal was very high (40.26%) because they studied a sample of gram-negative bacilli, in general, including non-fermenting gram-negative bacilli [95].
However, there can be no doubt that the worldwide prevalence of pAmpC-BL has increased, rising globally in the USA from 1.3% (2016) [32] to 3.42% (2019) [52] and in Egypt from 2.91% in E. coli isolates in 2019 [69] to 4.09% in 2020 [70]. In India, the prevalence in E. coli isolates increased from 4.44% in 2012 [81] to 11.10% in 2020 [96]. Major efforts are needed to control the spread of this type of beta-lactamase and avoid hospital/community outbreaks and endemic dissemination, such as that observed between 2010 and 2012 in Hungary, the first European country with endemic dissemination of a pAmpC-BL, specifically DHA-1 plasmid [134].
In Spain, the prevalence of pAmpC-BL in E. coli has been reported in various studies as 0.69% (2013) [43], 0.78% (2014) [45], 1.1% (2016) [49], and 2.02% (2016) [50], and the prevalence in K. pneumoniae was 1.02% in 2013 [43]. One of the studies in 2016 (50) suggested that pAmpC-BLs are the main mechanism of AmpC production in Spain.
Although the most frequent type of plasmid worldwide is CMY-2 of the CIT family, a high percentage of DHA-1 isolates has been reported in Asia, especially in China, where DHA-1 is the most commonly isolated plasmid [28,75,84,132]. DHA-1 is also the most frequent plasmid in K. pneumoniae isolates, whereas CMY-2 is the most common in E. coli isolates, as noted above. A striking finding is the predominance of FOX/MOX plasmids recently observed in Mozambique (2021), surpassing both CMY-2 and DHA-1 plasmids [60].
The presence of pAmpC-BL should be suspected when isolates have a BL resistance pattern that differs from their wild phenotype [121], given the well-documented validation of AmpC-BL screening detecting a reduced susceptibility to FOX [17]. Importantly, however, this screening procedure cannot detect AmpC-BLs of the ACC family, which are incapable of hydrolyzing FOX, and microorganisms that express these appear as susceptible to it in the antibiogram [5,17,103,114,116]. Reduced susceptibility to FOX may be due to not only AmpC-BL production but also to a reduced permeability of the external bacterial membrane [20,106]. Among the phenotypic methods reviewed, the “AmpC disk method” is a highly sensitive and specific method that can differentiate resistance to FOX due to the presence of AmpC-BL from that caused by a reduction in external membrane permeability [122], which cannot be achieved by the BA disk synergy method [20].
Phenotypic techniques are simple, generally inexpensive, rapid, and readily interpreted [112,114], favoring their incorporation in routine laboratory analyses to detect possible resistance-producing microorganisms. However, they are not capable of differentiating between pAmpC-BLs and cAmpC-BLs [3,17,19,98,115,116,119] or between different pAmpC-BL families [3]. Hence, a study of E. coli based on phenotypic methods alone would have high sensitivity but low specificity, because it may detect many E. coli isolates that are hyperproducers of chromosomal AmpC [98]. In Klebsiella spp., which lacks cAmpC-BL, a positive phenotypic result for AmpC would be confirmatory because it would imply the presence of pAmpC-BL [120,121]. One limitation of phenotypic methods using BA and its derivatives is that dimethyl sulfoxide is usually employed for their dilution, and this toxic substance needs to be handled with caution. However, their dilution in distilled water has also been described, resolving this problem [113,135]. A further limitation is that BA is not specific for AmpC, and positive results can result from the presence of ESBL and carbapenemases [121].
Few recommendations have been published on the application of these techniques, which require clear guidelines for their interpretation [104]. A good approach to the detection of AmpC may be to apply lower cutoff points than those habitually used for CAZ, ceftriaxone, and CTX. For instance, Agyekum et al. (2016) [136] described all isolates with CTX MIC > 1 mg/L as non-susceptible. Another shortcoming of phenotypic methods is that they are not all equally effective at detecting all AmpC families [20,137], and Ingram et al. (2011) found that inhibitors such as CLX or BA are more sensitive to DHA than CMY [114].
Proposed phenotypic methods that have demonstrated greatest diagnostic usefulness are those based on inhibitors. Thus, acceptable sensitivity and specificity values (>90%) are obtained using the double-disk synergy method with CLX + FOX [20,30,114] and the AmpC disk method [114,122]. The AmpC E-test has obtained the worst results, possibly because it contains CTT, showing lower sensitivity but higher specificity to detect AmpC [114].
The rapid fluorogenic method (1.5 h) recently developed by Park et al. (2020) has demonstrated high sensitivity and specificity to detect pAmpC-BL. It utilizes an antimicrobial bound to a fluorogenic substance that emits fluorescence in the presence of a beta-lactamase capable of its hydrolyzation. This method can also be combined with direct diagnostic techniques (Vitek2® or MALDI-TOF®) for the rapid detection of the bacterial species [138]. This represents an advancement in the development of novel methods for pAmpC-BL detection.
The coexistence of ESBL and AmpC poses a diagnostic challenge, given that ESBL resistance may go unnoticed in AmpC-producing organisms by presenting this resistance to CLAV. It is also possible that FOX resistance may be produced by a combination of ESBL production and reduced external membrane permeability [120]. A possible solution to the diagnostic challenge posed by the coexistence of ESBL and AmpC is to include FEP, which is not affected by the presence of AmpC, in ESBL screening along with CLAV [17,99]. In cases of ESBL and AmpC coexistence, BA is a more diagnostically valuable inhibitor [128]. Song et al. (2007) [139] modified the CLSI ESBL detection technique, which uses CLAV, by adding BA to CTX or CAZ disks and to CTX/CAZ disks with CLAV, producing CTX/CAZ+BA disks and CTX/CAZ+CLAV+BA disks. An increase of ≥3 mm in the halo of the CTX/CAZ+CLAV+BA versus CTX/CAZ+BA disk is considered positive for ESBL [113,135,140].
Genotypic methods are considered the gold standard techniques for the detection of AmpC resistances [3,30,114] and are able to differentiate between chromosomal and plasmid AmpC-BLs [98]. However, most of them are expensive, technically complex, and time-consuming methods that are mainly used in research and are reserved for doubtful cases in a clinical setting (e.g., E. coli isolates) [140]. Another major drawback is that they can detect ampC genes that are already known but not new mutations or AmpC families [16,98,112,115,132].
Based on the data gathered in this review, we developed an algorithm similar to that depicted in Figure 3. Accordingly, the presence of AmpC-BL should be suspected when there is resistance to cephamycins (MIC > 8 mg/L for FOX) and oxyimino-cephalosporins (pattern of resistance to CTX or CAZ). This helps avoid a search for AmpC-BL in ESBL-producing bacteria, which would meet the second but not the first criterion because they are susceptible to FOX. A phenotypic method should then be applied to confirm the presence of AmpC, with the double-disk synergy test being the most highly recommended approach. Finally, a PCR or a genotypic analysis should be carried out in doubtful cases to verify the presence/absence of AmpC-BL encoding genes, bearing in mind that some isolates present positivity in the double-disk method that even PCR cannot detect [102,135].

Figure 3.
Diagnostic algorithm for the phenotypic detection of AmpC-BL (based on data from the review). MIC: minimum inhibitory concentration; FOX: cefoxitin; CAZ: ceftazidime; BA: boronic acid; CLX: cloxacillin; PCR: polymerase chain reaction.
Regarding our screening proposal (see Section 2.2) for the phenotypic detection of AmpC-producing Enterobacteriaceae, test 2 obtained the best results. In comparison, Reuland et al. [30] obtained 91% sensitivity and 96% specificity using the double-disk synergy method with CLX in 66 isolates with reduced susceptibility to FOX and third-generation cephalosporins, and 85% sensitivity and 95% specificity when they applied the same method but with BA [30]. The use of CTT disks alone, and with the addition of BA as phenotypic confirmation, was recommended in a study with 635 isolates of Enterobacteriaceae not susceptible to FOX (MIC ≥ 32 mg/dL) [141]. In another study using the double-disk synergy method to test 255 isolates, the addition of CLX to a FOX disk, obtaining the best predictive values when the halo increase ≥4 mm, was considered positive, achieving 95% sensitivity and 95% specificity [20]. Finally, Polsfuss et al. used the double-disk synergy method in 305 isolates and described 97.2% sensitivity and 100% specificity [114]. With regard to other techniques, Black et al. used the AmpC disk to screen 140 isolates not susceptible to FOX and obtained 100% sensitivity and 98% specificity [122]. Ingram et al. compared different screening and confirmatory methods in a study of 246 isolates, concluding that the screening method with the AmpC disk obtained the best result, offering 95% sensitivity and 98% specificity [109]. In a sample of 125 pAmpC-BL-positive isolates, the CTT/CXT E-Test showed 98.6% sensitivity and 35.4% specificity, while the AmpC disk method obtained slightly lower sensitivity (96%) but higher specificity (58%) values [44]. Hence, the results achieved with test 2 are comparable to the best results described for screening phenotypic tests, with the added advantage of integrating this fourth disk in the screening test with FEP, FOX, and ETP disks, previously proposed by our group for the detection of microorganisms with ESBL and/or carbapenemase [9].
Test 2 yields lower values in the presence of ESBL. As noted above, the coexistence of AmpC and ESBL production hampers the phenotypic detection of both resistance mechanisms, and phenotypic methods are recommended with the addition of CLAV (AmpC inducer and ESBL inhibitor) and even genotypic methods for a definitive diagnosis [17]. Song et al. used BA as AmpC inhibitor in their study of 182 isolates, comparing CTX/CA/BA disks with CTX and/or CAZ/CA/BA with CAZ disks as well as CTX/CA/BA disks with CTX/BA disks and/or CAZ/CA/BA disks with CAZ/BA disks, reporting that both approaches markedly improved sensitivity and specificity values in comparison to the utilization of CA alone [139]. However, a review proposed the double-disk synergy method using CTX and CAZ with and without the addition of CLX as the optimal phenotypic confirmation test for AmpC in the presence of ESBL [119]. The diagnostic usefulness of test 2 in these isolates is enhanced by increasing the amount of CLX on the oxacillin disk.
Limitations
Studies with larger samples of AmpC-producing isolates are required to obtain more accurate predictive values. In common with other phenotypic techniques, our method cannot differentiate between the presence of plasmid or chromosomal AmpC except when the isolate is known to produce plasmid AmpC producer alone, as in the case of K. pneumoniae. In addition, the detection of pAmpC-BL is hampered by confluence with other resistance mechanisms such as ESBL production, porin loss, or E. coli producing ESAC beta-lactamases. Reference methods used for the detection of AmpC producers were the cefotetan/cefotetan-CLX E-Test and an increased CTX and CAZ MIC in the presence of CLAV, because the means required for genotypic identification of the AmpC resistance mechanism were not available.
5. Conclusions
There has been an increase in pAmpC-BL-producing isolates over the past 10 years, especially in the Asian continent, and CMY-2 producers are the most frequently responsible. Prevention of their spread requires the implementation of routine surveillance procedures that combine phenotypic and genotypic approaches (multiplex PCR). Among phenotypic screening methods, double-disk synergy and AmpC disk methods can be especially recommended for their predictive capacity. Our proposed screening method, which involves the addition of CLX on an oxacillin disk, is an easy-to-use and inexpensive test for the detection of AmpC-producing isolates, especially when there is no other resistance mechanism. Moreover, it can be combined on a single plate with a screening method for the detection of Enterobacteriaceae with ESBL and/or carbapenemases through the addition of FOX, FEP, and ETP disks.
Author Contributions
Conceptualization, J.G.-F.; Investigation, E.R.-G., J.C.C.-R. and J.G.-F.; Methodology, E.R.-G.; Supervision, J.G.-F.; Writing–original draft, E.R.-G. and J.C.C.-R.; Writing–review & editing, J.M.N.-M.and J.G.-F. All authors have read and agreed to the published version of the manuscript.
Funding
This research received no external funding.
Institutional Review Board Statement
Not applicable.
Informed Consent Statement
Not applicable.
Data Availability Statement
The data presented in this study are available in the main text.
Conflicts of Interest
The authors declare no conflict of interest.
References
- Livermore, D.M. Antibiotic resistance during and beyond COVID-19. JAC-Antimicrob Resist 2021, 3 (Suppl. 1), i5–i16. [Google Scholar] [CrossRef] [PubMed]
- Delgado-Valverde, M.; Sojo-Dorado, J.; Pascual, A.; Rodríguez-Baño, J. Clinical management of infections caused by multidrug-resistant Enterobacteriaceae. Ther. Adv. Infect. Dis. 2013, 1, 49–69. [Google Scholar] [CrossRef] [PubMed]
- Jacoby, G.A. AmpC beta-lactamases. Clin. Microbiol. Rev. 2009, 22, 161–182. [Google Scholar] [CrossRef] [PubMed]
- Philippon, A.; Arlet, G.; Jacoby, G.A. Plasmid-determined AmpC-type beta-lactamases. Antimicrob Agents Chemother. 2002, 46, 1–11. [Google Scholar] [CrossRef] [PubMed]
- Walther-Rasmussen, J.; Høiby, N. Plasmid-borne AmpC beta-lactamases. Can. J. Microbiol. 2002, 48, 79–93. [Google Scholar] [CrossRef] [PubMed]
- Soria-Segarra, C.; Delgado-Valverde, M.; Serrano-García, M.L.; López-Hernández, I.; Navarro-Marí, J.M.; Gutiérrez-Fernández, J. Infections in patients colonized with carbapenem-resistant Gram-negative bacteria in a medium Spanish city. Rev. Esp. Quimioter. Publ. Of. Soc. Esp. Quimioter. 2021, 34, 50–58. [Google Scholar] [CrossRef] [PubMed]
- Cano-Martín, E.; Portillo-Calderón, I.; Pérez-Palacios, P.; Navarro-Marí, J.M.; Fernández-Sierra, M.A.; Gutiérrez-Fernández, J. A Study in a Regional Hospital of a Mid-Sized Spanish City Indicates a Major Increase in Infection/Colonization by Carbapenem-Resistant Bacteria, Coinciding with the COVID-19 Pandemic. Antibiotics 2021, 10, 1127. [Google Scholar] [CrossRef] [PubMed]
- del Castillo, M.C.; López-Cerezo, L.; Casal, M.; Pascual, A. Evaluation of chromID ESBL medium for detecting carriers of extended-spectrum beta-lactamase-producing enterobacteriaceae. Enferm. Infecc. Microbiol. Clin. 2011, 29, 471–472. [Google Scholar] [CrossRef]
- Montiel-Riquelme, F.; Calatrava-Hernández, E.; Gutiérrez-Soto, M.; Expósito-Ruiz, M.; Navarro-Marí, J.M.; Gutiérrez-Fernández, J. Clinical Relevance of Antibiotic Susceptibility Profiles for Screening Gram-negative Microorganisms Resistant to Beta-Lactam Antibiotics. Microorganisms 2020, 8, 1555. [Google Scholar] [CrossRef]
- De Oliveira, D.V.; Van Der Sand, S.T. Phenotypic Tests for the Detection of β-Lactamase-Producing Enterobacteriaceae Isolated from Different Environments. Curr. Microbiol. 2016, 73, 132–138. [Google Scholar] [CrossRef]
- EUCAST: EUCAST. Available online: https://www.eucast.org/ (accessed on 2 November 2021).
- Bush, K.; Bradford, P.A. Epidemiology of β-Lactamase-Producing Pathogens. Clin. Microbiol. Rev. 2020, 33, e00047-19. [Google Scholar] [CrossRef] [PubMed]
- Carattoli, A. Resistance plasmid families in Enterobacteriaceae. Antimicrob Agents Chemother. 2009, 53, 2227–2238. [Google Scholar] [CrossRef] [PubMed]
- Pfeifer, Y.; Cullik, A.; Witte, W. Resistance to cephalosporins and carbapenems in Gram-negative bacterial pathogens. Int. J. Med. Microbiol. IJMM 2010, 300, 371–379. [Google Scholar] [CrossRef] [PubMed]
- Bauernfeind, A.; Chong, Y.; Lee, K. Plasmid-encoded AmpC beta-lactamases: How far have we gone 10 years after the discovery? Yonsei Med. J. 1998, 39, 520–525. [Google Scholar] [CrossRef] [PubMed]
- Pérez-Pérez, F.J.; Hanson, N.D. Detection of plasmid-mediated AmpC beta-lactamase genes in clinical isolates by using multiplex PCR. J. Clin. Microbiol. 2002, 40, 2153–2162. [Google Scholar] [CrossRef] [PubMed]
- Meini, S.; Tascini, C.; Cei, M.; Sozio, E.; Rossolini, G.M. AmpC β-lactamase-producing Enterobacterales: What a clinician should know. Infection 2019, 47, 363–375. [Google Scholar] [CrossRef] [PubMed]
- Su, L.-H.; Chu, C.; Cloeckaert, A.; Chiu, C.-H. An epidemic of plasmids? Dissemination of extended-spectrum cephalosporinases among Salmonella and other Enterobacteriaceae. FEMS Immunol. Med. Microbiol. 2008, 52, 155–168. [Google Scholar] [CrossRef] [PubMed]
- Tan, T.Y.; Ng, S.Y.; Teo, L.; Koh, Y.; Teok, C.H. Detection of plasmid-mediated AmpC in Escherichia coli, Klebsiella pneumoniae and Proteus mirabilis. J. Clin. Pathol. 2008, 61, 642–644. [Google Scholar] [CrossRef] [PubMed]
- Tan, T.Y.; Ng, L.S.Y.; He, J.; Koh, T.H.; Hsu, L.Y. Evaluation of screening methods to detect plasmid-mediated AmpC in Escherichia coli, Klebsiella pneumoniae, and Proteus mirabilis. Antimicrob. Agents. Chemother. 2009, 53, 146–149. [Google Scholar] [CrossRef]
- Yamasaki, K.; Komatsu, M.; Abe, N.; Fukuda, S.; Miyamoto, Y.; Higuchi, T.; Ono, T.; Nishio, H.; Sueyoshi, N.; Kida, K.; et al. Laboratory surveillance for prospective plasmid-mediated AmpC beta-lactamases in the Kinki region of Japan. J. Clin. Microbiol. 2010, 48, 3267–3273. [Google Scholar] [CrossRef][Green Version]
- Harris, P.N.A.; Ben Zakour, N.L.; Roberts, L.W.; Wailan, A.M.; Zowawi, H.M.; Tambyah, P.A.; Lye, D.; Jureen, R.; Lee, T.H.; Yin, M.; et al. Whole genome analysis of cephalosporin-resistant Escherichia coli from bloodstream infections in Australia, New Zealand and Singapore: High prevalence of CMY-2 producers and ST131 carrying blaCTX-M-15 and blaCTX-M-27. J. Antimicrob. Chemother. 2018, 73, 634–642. [Google Scholar] [CrossRef] [PubMed]
- Paterson, D.L. Resistance in gram-negative bacteria: Enterobacteriaceae. Am. J. Med. 2006, 119 (Suppl. 1), S20–S28, discussion S62–S70. [Google Scholar] [CrossRef] [PubMed]
- Kang, C.-I.; Pai, H.; Kim, S.-H.; Kim, H.-B.; Kim, E.-C.; Oh, M.; Choe, K. Cefepime and the inoculum effect in tests with Klebsiella pneumoniae producing plasmid-mediated AmpC-type beta-lactamase. J. Antimicrob. Chemother. 2004, 54, 1130–1133. [Google Scholar] [CrossRef] [PubMed]
- Rodríguez-Baño, J.; Miró, E.; Villar, M.; Coelho, A.; Gozalo, M.; Borrell, N.; Bou, G.; Conejo, M.C.; Pomar, V.; Aracil, B.; et al. Colonisation and infection due to Enterobacteriaceae producing plasmid-mediated AmpC β-lactamases. J. Infect. 2012, 64, 176–183. [Google Scholar] [CrossRef] [PubMed]
- Lee, C.-H.; Lee, Y.-T.; Kung, C.-H.; Ku, W.-W.; Kuo, S.-C.; Chen, T.-L.; Fung, C.-P. Risk factors of community-onset urinary tract infections caused by plasmid-mediated AmpC β-lactamase-producing Enterobacteriaceae. J. Microbiol. Immunol. Infect. 2015, 48, 269–275. [Google Scholar] [CrossRef] [PubMed]
- Pascual, V.; Ortiz, G.; Simó, M.; Alonso, N.; Garcia, M.C.; Xercavins, M.; Rivera, A.; Morera, M.A.; Miró, E.; Espejo, E.; et al. Epidemiology and risk factors for infections due to AmpC β-lactamase-producing Escherichia coli. J. Antimicrob. Chemother. 2015, 70, 899–904. [Google Scholar] [CrossRef] [PubMed]
- Gude, M.J.; Seral, C.; Saenz, Y.; González-Domínguez, M.; Torres, C.; Castillo, F.J. Evaluation of four phenotypic methods to detect plasmid-mediated AmpC β-lactamases in clinical isolates. Eur. J. Clin. Microbiol. 2012, 31, 2037–2043. [Google Scholar] [CrossRef] [PubMed]
- Pai, H.; Kang, C.-I.; Byeon, J.-H.; Lee, K.-D.; Park, W.B.; Kim, H.-B.; Kim, E.-C.; Oh, M.-D.; Choe, K.-W. Epidemiology and clinical features of bloodstream infections caused by AmpC-type-beta-lactamase-producing Klebsiella pneumoniae. Antimicrob. Agents. Chemother. 2004, 48, 3720–3728. [Google Scholar] [CrossRef]
- Reuland, E.A.; Hays, J.P.; de Jongh, D.M.C.; Abdelrehim, E.; Willemsen, I.; Kluytmans, J.A.J.W.; Savelkoul, P.H.M.; Vandenbroucke-Grauls, C.M.J.E.; al Naiemi, N. Detection and Occurrence of Plasmid-Mediated AmpC in Highly Resistant Gram-Negative Rods. PLoS ONE 2014, 9, e91396. [Google Scholar] [CrossRef]
- Jørgensen, R.L.; Nielsen, J.B.; Friis-Møller, A.; Fjeldsøe-Nielsen, H.; Schønning, K. Prevalence and molecular characterization of clinical isolates of Escherichia coli expressing an AmpC phenotype. J. Antimicrob. Chemother. 2010, 65, 460–464. [Google Scholar] [CrossRef]
- Suwantarat, N.; Logan, L.K.; Carroll, K.C.; Bonomo, R.A.; Simner, P.J.; Rudin, S.D.; Milstone, A.M.; Tekle, T.; Ross, T.; Tamma, P.D. The Prevalence and Molecular Epidemiology of Multidrug-Resistant Enterobacteriaceae Colonization in a Pediatric Intensive Care Unit. Infect. Control. Hosp. Epidemiol. 2016, 37, 535–543. [Google Scholar] [CrossRef]
- Voets, G.M.; Platteel, T.N.; Fluit, A.C.; Scharringa, J.; Schapendonk, C.M.; Stuart, J.C.; Bonten, M.J.M.; Leverstein-van Hall, M.A.; Hall, M.A.L.; National ESBL Surveillance Working Group. Population distribution of Beta-lactamase conferring resistance to third-generation cephalosporins in human clinical Enterobacteriaceae in the Netherlands. PLoS ONE 2012, 7, e52102. [Google Scholar] [CrossRef] [PubMed][Green Version]
- Gómara, M.; López-Calleja, A.I.; Iglesia, B.M.P.V.; Cerón, I.F.; López, A.R.; Pinilla, M.J.R. Detection of carbapenemases and other mechanisms of enzymatic resistance to β-lactams in Enterobacteriaceae with diminished susceptibility to carbapenems in a tertiary care hospital. Enfermedades Infecc. Microbiol. Clin. Engl. Ed. 2018, 36, 296–301. [Google Scholar] [CrossRef] [PubMed]
- Courpon-Claudinon, A.; Lefort, A.; Panhard, X.; Clermont, O.; Dornic, Q.; Fantin, B.; Mentré, F.; Wolff, M.; Denamur, E.; Branger, C.; et al. Bacteraemia caused by third-generation cephalosporin-resistant Escherichia coli in France: Prevalence, molecular epidemiology and clinical features. Clin. Microbiol. Infect. 2011, 17, 557–565. [Google Scholar] [CrossRef] [PubMed][Green Version]
- Zhou, X.; García-Cobos, S.; Ruijs, G.J.H.M.; Kampinga, G.A.; Arends, J.P.; Borst, D.M.; Möller, L.V.; Holman, N.D.; Schuurs, T.A.; Bruijnesteijn van Coppenraet, L.E.; et al. Epidemiology of Extended-Spectrum β-Lactamase-Producing E. coli and Vancomycin-Resistant Enterococci in the Northern Dutch-German Cross-Border Region. Front. Microbiol. 2017, 8, 1914. [Google Scholar] [CrossRef] [PubMed]
- Ribeiro, T.G.; Novais, Â.; Rodrigues, C.; Nascimento, R.; Freitas, F.; Machado, E.; Peixe, L. Dynamics of clonal and plasmid backgrounds of Enterobacteriaceae producing acquired AmpC in Portuguese clinical settings over time. Int. J. Antimicrob. Agents. 2019, 53, 650–656. [Google Scholar] [CrossRef] [PubMed]
- den Drijver, E.; Verweij, J.J.; Verhulst, C.; Oome, S.; Soer, J.; Willemsen, I.; Schrauwen, E.J.A.; Kluytmans-van den Bergh, M.F.Q.; Kluytmans, J.A.J.W. Decline in AmpC β-lactamase-producing Escherichia coli in a Dutch teaching hospital (2013–2016). PLoS ONE 2018, 13, e0204864. [Google Scholar] [CrossRef] [PubMed]
- Findlay, J.; Gould, V.C.; North, P.; Bowker, K.E.; Williams, M.O.; MacGowan, A.P.; Avison, M.B. Characterization of cefotaxime-resistant urinary Escherichia coli from primary care in South-West England 2017–18. J. Antimicrob. Chemother. 2019, 75, 65–71. [Google Scholar] [CrossRef]
- Li, Y.; Cassidy, F.; Salmon, A.; Keating, D.; Herra, C.; Schaffer, K. Detection and epidemiology of plasmid-mediated AmpC β-lactamase producing Escherichia coli in two Irish tertiary care hospitals. J. Glob. Antimicrob. Resist. 2015, 3, 242–246. [Google Scholar] [CrossRef][Green Version]
- Seiffert, S.N.; Hilty, M.; Kronenberg, A.; Droz, S.; Perreten, V.; Endimiani, A. Extended-spectrum cephalosporin-resistant Escherichia coli in community, specialized outpatient clinic and hospital settings in Switzerland. J. Antimicrob. Chemother. 2013, 68, 2249–2254. [Google Scholar] [CrossRef]
- Illiaquer, M.; Caroff, N.; Bémer, P.; Aubin, G.G.; Juvin, M.-E.; Lepelletier, D.; Reynaud, A.; Corvec, S. Occurrence and molecular characterization of Klebsiella pneumoniae ST37 clinical isolates producing plasmid-mediated AmpC recovered over a 3-year period. Diagn. Microbiol. Infect. Dis. 2012, 74, 95–97. [Google Scholar] [CrossRef] [PubMed]
- Miró, E.; Agüero, J.; Larrosa, M.N.; Fernández, A.; Conejo, M.C.; Bou, G.; González-López, J.J.; Lara, N.; Martínez-Martínez, L.; Oliver, A.; et al. Prevalence and molecular epidemiology of acquired AmpC β-lactamases and carbapenemases in Enterobacteriaceae isolates from 35 hospitals in Spain. Eur. J. Clin. Microbiol. Infect. Dis. 2013, 32, 253–259. [Google Scholar] [CrossRef] [PubMed]
- Gude, M.J.; Seral, C.; Sáenz, Y.; Cebollada, R.; González-Domínguez, M.; Torres, C.; Castillo, F.J. Molecular epidemiology, resistance profiles and clinical features in clinical plasmid-mediated AmpC-producing Enterobacteriaceae. Int. J. Med. Microbiol. IJMM 2013, 303, 553–557. [Google Scholar] [CrossRef] [PubMed]
- Galán-Sánchez, F.; Aznar-Marín, P.; Marín-Casanova, P.; Rodríguez-Iglesias, M. Diversity of bla genes and low incidence of CTX-M in plasmid-mediated AmpC-producing Escherichia coli clinical isolates. APMIS Acta. Pathol. Microbiol. Immunol. Scand. 2014, 122, 796–799. [Google Scholar] [CrossRef] [PubMed]
- Jones-Dias, D.; Manageiro, V.; Ferreira, E.; Louro, D.; Antibiotic Resistance Surveillance Program in Portugal (ARSIP) participants; Caniça, M. Diversity of extended-spectrum and plasmid-mediated AmpC β-lactamases in Enterobacteriaceae isolates from portuguese health care facilities. J. Microbiol. 2014, 52, 496–503. [Google Scholar] [CrossRef] [PubMed]
- Reuland, E.A.; Halaby, T.; Hays, J.P.; de Jongh, D.M.C.; Snetselaar, H.D.R.; van Keulen, M.; Elders, P.J.M.; Savelkoul, P.H.M.; Vandenbroucke-Grauls, C.M.J.E.; Al Naiemi, N. Plasmid-mediated AmpC: Prevalence in community-acquired isolates in Amsterdam, the Netherlands, and risk factors for carriage. PLoS ONE 2015, 10, e0113033. [Google Scholar] [CrossRef] [PubMed]
- Ibrahimagić, A.; Bedenić, B.; Kamberović, F.; Uzunović, S. High prevalence of CTX-M-15 and first report of CTX-M-3, CTX-M-22, CTX-M-28 and plasmid-mediated AmpC beta-lactamase producing Enterobacteriaceae causing urinary tract infections in Bosnia and Herzegovina in hospital and community settings. J. Infect. Chemother. 2015, 21, 363–369. [Google Scholar] [CrossRef] [PubMed]
- Alonso, N.A.; Miro, E.; Pascual, V.; Rivera, A.; Simó, M.; Garcia, M.C.; Xercavins, M.; Morera, M.A.; Espejo, E.; Gurguí, M.; et al. Molecular characterisation of acquired and overproduced chromosomal blaAmpC in Escherichia coli clinical isolates. Int. J. Antimicrob. Agents 2015, 47, 62–68. [Google Scholar] [CrossRef] [PubMed]
- Pascual, V.; Alonso, N.; Simó, M.; Ortiz, G.; Garcia, M.C.; Xercavins, M.; Rivera, A.; Morera, M.A.; Miró, E.; Espejo, E.; et al. Bloodstream infections caused by Escherichia coli producing AmpC β-lactamases: Epidemiology and clinical features. Eur. J. Clin. Microbiol. 2016, 35, 1997–2003. [Google Scholar] [CrossRef]
- Rohde, A.M.; Zweigner, J.; Wiese-Posselt, M.; Schwab, F.; Behnke, M.; Kola, A.; Schröder, W.; Peter, S.; Tacconelli, E.; Wille, T.; et al. Prevalence of third-generation cephalosporin-resistant Enterobacterales colonization on hospital admission and ESBL genotype-specific risk factors: A cross-sectional study in six German university hospitals. J. Antimicrob. Chemother. 2020, 75, 1631–1638. [Google Scholar] [CrossRef]
- Tamma, P.D.; Sharara, S.L.; Pana, Z.D.; Amoah, J.; Fisher, S.L.; Tekle, T.; Doi, Y.; Simner, P.J. Molecular Epidemiology of Ceftriaxone Non-Susceptible Enterobacterales Isolates in an Academic Medical Center in the United States. Open Forum. Infect. Dis. 2019, 6, ofz353. [Google Scholar] [CrossRef]
- Park, Y.S.; Adams-Haduch, J.M.; Shutt, K.; Iii, D.M.Y.; Johnson, L.E.; Hingwe, A.; Lewis, J.S.; Jorgensen, J.H.; Doi, Y. Clinical and Microbiologic Characteristics of Cephalosporin-Resistant Escherichia coli at Three Centers in the United States. Antimicrob. Agents Chemother. 2012, 56, 1870–1876. [Google Scholar] [CrossRef] [PubMed]
- Paniagua-Contreras, G.L.; Monroy-Pérez, E.; Bautista, A.; Reyes, R.; Vicente, A.; Vaca-Paniagua, F.; Díaz, C.E.; Martínez, S.; Domínguez, P.; García, L.R.; et al. Multiple antibiotic resistances and virulence markers of uropathogenic Escherichia coli from Mexico. Pathog. Glob. Health 2018, 112, 415–420. [Google Scholar] [CrossRef] [PubMed]
- Logan, L.K.; Hujer, A.M.; Marshall, S.H.; Domitrovic, T.N.; Rudin, S.D.; Zheng, X.; Qureshi, N.K.; Hayden, M.K.; Scaggs, F.A.; Karadkhele, A.; et al. Analysis of β-Lactamase Resistance Determinants in Enterobacteriaceae from Chicago Children: A Multicenter Survey. Antimicrob. Agents Chemother. 2016, 60, 3462–3469. [Google Scholar] [CrossRef] [PubMed]
- Tellevik, M.G.; Blomberg, B.; Kommedal, Ø.; Maselle, S.Y.; Langeland, N.; Moyo, S.J. High Prevalence of Faecal Carriage of ESBL-Producing Enterobacteriaceae among Children in Dar es Salaam, Tanzania. PLoS ONE 2016, 11, e0168024. [Google Scholar] [CrossRef] [PubMed]
- Barguigua, A.; El Otmani, F.; Talmi, M.; Reguig, A.; Jamali, L.; Zerouali, K.; Timinouni, M. Prevalence and genotypic analysis of plasmid-mediated β-lactamases among urinary Klebsiella pneumoniae isolates in Moroccan community. J. Antibiot. 2012, 66, 11–16. [Google Scholar] [CrossRef] [PubMed]
- Helmy, M.M.; Wasfi, R. Phenotypic and molecular characterization of plasmid mediated AmpC β-lactamases among Escherichia coli, Klebsiella spp., and Proteus mirabilis isolated from urinary tract infections in Egyptian hospitals. BioMed Res. Int. 2014, 2014, 171548. [Google Scholar] [CrossRef] [PubMed]
- Yusuf, I.; Arzai, A.; Haruna, M.; Sharif, A.; Getso, M. Detection of multi drug resistant bacteria in major hospitals in Kano, North-West, Nigeria. Braz. J. Microbiol. 2014, 45, 791–798. [Google Scholar] [CrossRef]
- Estaleva, C.E.L.; Zimba, T.F.; Sekyere, J.O.; Govinden, U.; Chenia, H.Y.; Simonsen, G.S.; Haldorsen, B.; Essack, S.Y.; Sundsfjord, A. High prevalence of multidrug resistant ESBL- and plasmid mediated AmpC-producing clinical isolates of Escherichia coli at Maputo Central Hospital, Mozambique. BMC Infect. Dis. 2021, 21, 16. [Google Scholar] [CrossRef] [PubMed]
- Zorgani, A.; Daw, H.; Sufya, N.; Bashein, A.; Elahmer, O.; Chouchani, C. Co-Occurrence of Plasmid-Mediated AmpC β-Lactamase Activity among Klebsiella pneumoniae and Escherichia Coli. Open Microbiol. J. 2017, 11, 195–202. [Google Scholar] [CrossRef] [PubMed]
- Ogbolu, D.; Daini, O.; Ogunledun, A.; Alli, A.; Webber, M. High levels of multidrug resistance in clinical isolates of Gram-negative pathogens from Nigeria. Int. J. Antimicrob. Agents 2011, 37, 62–66. [Google Scholar] [CrossRef]
- Barguigua, A.; El Otmani, F.; Talmi, M.; Zerouali, K.; Timinouni, M. Prevalence and types of extended spectrum β-lactamases among urinary Escherichia coli isolates in Moroccan community. Microb. Pathog. 2013, 61–62, 16–22. [Google Scholar] [CrossRef] [PubMed]
- Nakaye, M.; Bwanga, F.; Itabangi, H.; Stanley, I.J.; Bashir, M.; Bazira, J. AmpC-BETA Lactamases among Enterobacteriaceae Isolated at a Tertiary Hospital, South Western Uganda. Br. Biotechnol. J. 2014, 4, 1026–1036. [Google Scholar] [CrossRef] [PubMed]
- Gharout-Sait, A.; Touati, A.; Guillard, T.; Brasme, L.; De Champs, C. Molecular characterization and epidemiology of cefoxitin resistance among Enterobacteriaceae lacking inducible chromosomal ampC genes from hospitalized and non-hospitalized patients in Algeria: Description of new sequence type in Klebsiella pneumoniae isolates. Braz. J. Infect. Dis. 2015, 19, 187–195. [Google Scholar] [PubMed]
- Chérif, T.; Saidani, M.; Decré, D.; Boutiba-Ben Boubaker, I.; Arlet, G. Cooccurrence of Multiple AmpC β-Lactamases in Escherichia coli, Klebsiella pneumoniae, and Proteus mirabilis in Tunisia. Antimicrob. Agents. Chemother. 2016, 60, 4–51. [Google Scholar] [CrossRef] [PubMed]
- Ben Tanfous, F.; Achour, W.; Raddaoui, A.; Ben Hassen, A. Molecular characterisation and epidemiology of extended-spectrum β-lactamase-producing Klebsiella pneumoniae isolates from immunocompromised patients in Tunisia. J. Glob. Antimicrob. Resist. 2018, 13, 154–160. [Google Scholar] [CrossRef] [PubMed]
- Ben Tanfous, F.; Raddaoui, A.; Chebbi, Y.; Achour, W. Epidemiology and molecular characterisation of colistin-resistant Klebsiella pneumoniae isolates from immunocompromised patients in Tunisia. Int. J. Antimicrob. Agents 2018, 52, 861–865. [Google Scholar] [CrossRef]
- Rensing, K.L.; Abdallah, H.M.; Koek, A.; Elmowalid, G.A.; Vandenbroucke-Grauls, C.M.J.E.; Al Naiemi, N.; Van Dijk, K. Prevalence of plasmid-mediated AmpC in Enterobacteriaceae isolated from humans and from retail meat in Zagazig, Egypt. Antimicrob. Resist. Infect. Control 2019, 8, 45. [Google Scholar] [CrossRef] [PubMed]
- Mohamed, E.S.; Khairy, R.M.M.; Abdelrahim, S.S. Prevalence and molecular characteristics of ESBL and AmpC β -lactamase producing Enterobacteriaceae strains isolated from UTIs in Egypt. Antimicrob. Resist. Infect. Control 2020, 9, 198. [Google Scholar] [CrossRef]
- Luk, S.; Wong, W.-K.; Ho, A.Y.-M.; Yu, K.C.-H.; To, W.-K.; Ng, T.-K. Clinical features and molecular epidemiology of plasmid-mediated DHA-type AmpC β-lactamase-producing Klebsiella pneumoniae blood culture isolates, Hong Kong. J. Glob. Antimicrob. Resist. 2016, 7, 37–42. [Google Scholar] [CrossRef] [PubMed]
- Mohamudha Parveen, R.; Harish, B.N.; Parija, S.C. Ampc Beta lactamases among gram negative clinical isolates from a tertiary hospital, South India. Braz. J. Microbiol. Publ. Braz. Soc. Microbiol. 2010, 41, 596–602. [Google Scholar] [CrossRef] [PubMed]
- Harish, B.; Mohamudha, P.R.; Parija, S.C. Molecular description of plasmid-mediated AmpC β-lactamases among nosocomial isolates of Escherichia coli & Klebsiella pneumoniae from six different hospitals in India. Indian J. Med Res. 2012, 135, 114–119. [Google Scholar]
- Habeeb, M.A.; Haque, A.; Nematzadeh, S.; Iversen, A.; Giske, C.G. High prevalence of 16S rRNA methylase RmtB among CTX-M extended-spectrum β-lactamase-producing Klebsiella pneumoniae from Islamabad, Pakistan. Int. J. Antimicrob. Agents 2013, 41, 524–526. [Google Scholar] [CrossRef] [PubMed]
- Hou, X.-H.; Song, X.-Y.; Ma, X.-B.; Zhang, S.-Y.; Zhang, J.-Q. Molecular characterization of multidrug-resistant Klebsiella pneumoniae isolates. Braz. J. Microbiol. 2015, 46, 759–768. [Google Scholar] [CrossRef] [PubMed]
- Yoo, J.S.; Byeon, J.; Yang, J.; Yoo, J.I.; Chung, G.T.; Lee, Y.S. High prevalence of extended-spectrum beta-lactamases and plasmid-mediated AmpC beta-lactamases in Enterobacteriaceae isolated from long-term care facilities in Korea. Diagn. Microbiol. Infect. Dis. 2010, 67, 261–265. [Google Scholar] [CrossRef] [PubMed]
- Singtohin, S.; Chanawong, A.; Lulitanond, A.; Sribenjalux, P.; Auncharoen, A.; Kaewkes, W.; Songsri, J.; Pienthaweechai, K. CMY-2, CMY-8b, and DHA-1 plasmid-mediated AmpC β-lactamases among clinical isolates of Escherichia coli and Klebsiella pneumoniae from a university hospital, Thailand. Diagn. Microbiol. Infect. Dis. 2010, 68, 271–277. [Google Scholar] [CrossRef] [PubMed]
- Manoharan, A.; Sugumar, M.; Kumar, A.; Jose, H.; Mathai, D.; Khilnani, G.C.; Kapil, A.; Francis, G.; Radhakrishnan, K.; Dutta, T.K.; et al. Phenotypic & molecular characterization of AmpC β-lactamases among Escherichia coli, Klebsiella spp. & Enterobacter spp. from five Indian Medical Centers. Indian J. Med. Res. 2012, 135, 359–364. [Google Scholar] [PubMed]
- Matsumura, Y.; Yamamoto, M.; Higuchi, T.; Komori, T.; Tsuboi, F.; Hayashi, A.; Sugimoto, Y.; Hotta, G.; Matsushima, A.; Ngao, M.; et al. Prevalence of plasmid-mediated AmpC β-lactamase-producing Escherichia coli and spread of the ST131 clone among extended-spectrum β-lactamase-producing E. coli in Japan. Int. J. Antimicrob. Agents 2012, 40, 158–162. [Google Scholar] [CrossRef]
- Gupta, V.; Kumarasamy, K.; Gulati, N.; Garg, R.; Krishnan, P.; Chander, J. AmpC β-lactamases in nosocomial isolates of Klebsiella pneumoniae from India. Indian J. Med Res. 2012, 136, 237–241. [Google Scholar]
- Sasirekha, B.; Shivakumar, S. Occurrence of Plasmid-Mediated AmpC β-Lactamases Among Escherichia coli and Klebsiella pneumoniae Clinical Isolates in a Tertiary Care Hospital in Bangalore. Indian J. Microbiol. 2011, 52, 174–179. [Google Scholar] [CrossRef]
- Shafiq, M.; Rahman, H.; Qasim, M.; Ayub, N.; Hussain, S.; Khan, J.; Naeem, M. Prevalence of plasmid-mediated AmpC β-lactamases in Escherichia coli and Klebsiella pneumonia at tertiary care hospital of Islamabad, Pakistan. Eur. J. Microbiol. Immunol. 2013, 3, 267–271. [Google Scholar] [CrossRef] [PubMed]
- Azimi, L.; Erajiyan, G.; Talebi, M.; Owlia, P.; Bina, M.; Shojaie, A.; Lari, A.R. Phenotypic and Molecular Characterization of Plasmid Mediated AmpC among Clinical Isolates of Klebsiella pneumoniae Isolated from Different Hospitals in Tehran. J. Clin. Diagn. Res. 2015, 9, DC01–DC03. [Google Scholar] [CrossRef] [PubMed]
- Liu, X.; Liu, Y. Detection of plasmid-mediated AmpC β-lactamase in Escherichia coli. Biomed. Rep. 2016, 4, 687–690. [Google Scholar] [CrossRef] [PubMed]
- Liu, X.-Q.; Liu, Y.-R. Detection and genotype analysis of AmpC β-lactamase in Klebsiella pneumoniae from tertiary hospitals. Exp. Ther. Med. 2016, 12, 480–484. [Google Scholar] [CrossRef] [PubMed][Green Version]
- Ghosh, B.; Mukherjee, M. Emergence of co-production of plasmid-mediated AmpC beta-lactamase and ESBL in cefoxitin-resistant uropathogenic Escherichia coli. Eur. J. Clin. Microbiol. 2016, 35, 1449–1454. [Google Scholar] [CrossRef] [PubMed]
- Sadeghi, M.R.; Ghotaslou, R.; Akhi, M.T.; Asgharzadeh, M.; Hasani, A. Molecular characterization of extended-spectrum β-lactamase, plasmid-mediated AmpC cephalosporinase and carbapenemase genes among Enterobacteriaceae isolates in five medical centres of East and West Azerbaijan, Iran. J. Med Microbiol. 2016, 65, 1322–1331. [Google Scholar] [CrossRef] [PubMed]
- Baljin, B.; Baldan, G.; Chimeddorj, B.; Tulgaa, K.; Gunchin, B.; Sandag, T.; Pfeffer, K.; MacKenzie, C.R.; Wendel, A.F. Faecal Carriage of Gram-Negative Multidrug-Resistant Bacteria among Patients Hospitalized in Two Centres in Ulaanbaatar, Mongolia. PLoS ONE 2016, 11, e0168146. [Google Scholar] [CrossRef]
- Noguchi, T.; Matsumura, Y.; Yamamoto, M.; Nagao, M.; Takakura, S.; Ichiyama, S. Clinical and microbiologic characteristics of cefotaxime-non-susceptible Enterobacteriaceae bacteremia: A case control study. BMC Infect. Dis. 2017, 17, 44. [Google Scholar] [CrossRef]
- Abdalhamid, B.; Albunayan, S.; Shaikh, A.; Elhadi, N.; Aljindan, R. Prevalence study of plasmid-mediated AmpC β-lactamases in Enterobacteriaceae lacking inducible ampC from Saudi hospitals. J. Med Microbiol. 2017, 66, 1286–1290. [Google Scholar] [CrossRef]
- Nishimura, F.; Morinaga, Y.; Akamatsu, N.; Matsuda, J.; Kaku, N.; Takeda, K.; Uno, N.; Kosai, K.; Hasegawa, H.; Yanagihara, K. Plasmid-Mediated AmpC β-Lactamase and Underestimation of Extended-Spectrum β-Lactamase in Cefepime-Susceptible Elevated-Ceftazidime-MIC Enterobacteriaceae Isolates. Jpn. J. Infect. Dis. 2018, 71, 281–285. [Google Scholar] [CrossRef] [PubMed]
- Kim, K.G.; Jeong, J.; Kim, M.J.; Park, D.W.; Shin, J.H.; Park, H.J.; Chung, J.K.; Kee, H.Y. Prevalence and molecular epidemiology of ESBLs, plasmid-determined AmpC-type β-lactamases and carbapenemases among diarrhoeagenic Escherichia coli isolates from children in Gwangju, Korea: 2007-16. J. Antimicrob. Chemother. 2019, 74, 2181–2187. [Google Scholar] [CrossRef] [PubMed]
- Rizi, K.S.; Mosavat, A.; Youssefi, M.; Jamehdar, S.A.; Ghazvini, K.; Safdari, H.; Amini, Y.; Farsiani, H. High prevalence of blaCMY AmpC beta-lactamase in ESBL co-producing Escherichia coli and Klebsiella spp. clinical isolates in the northeast of Iran. J. Glob. Antimicrob. Resist. 2020, 22, 477–482. [Google Scholar] [CrossRef] [PubMed]
- Thapa Shrestha, U.; Shrestha, S.; Adhikari, N.; Rijal, K.R.; Shrestha, B.; Adhikari, B.; Banjara, M.R.; Ghimire, P. Plasmid Profiling and Occurrence of β-Lactamase Enzymes in Multidrug-Resistant Uropathogenic Escherichia coli in Kathmandu, Nepal. Infect. Drug Resist. 2020, 13, 1905–1917. [Google Scholar] [CrossRef] [PubMed]
- Aryal, S.C.; Upreti, M.K.; Sah, A.K.; Ansari, M.; Nepal, K.; Dhungel, B.; Adhikari, N.; Lekhak, B.; Rijal, K.R. Plasmid-Mediated AmpC β-Lactamase CITM and DHAM Genes Among Gram-Negative Clinical Isolates. Infect. Drug Resist. 2020, 13, 4249–4261. [Google Scholar] [CrossRef] [PubMed]
- Bala, R.; Singh, V.A.; Gupta, N.; Rakshit, P. Prevalence, multidrug-resistance and risk factors for AmpC β-lactamases producing Escherichia coli from hospitalized patients. J. Infect. Dev. Ctries. 2020, 14, 1466–1469. [Google Scholar] [CrossRef] [PubMed]
- Conejo, M.C.; Mata, C.; Navarro, F.; Pascual, A.; GEMARA Collaborative Group. Detection and reporting beta-lactam resistance phenotypes in Escherichia coli and Klebsiella pneumoniae: A multicenter proficiency study in Spain. Diagn. Microbiol. Infect. Dis. 2008, 62, 317–325. [Google Scholar] [CrossRef] [PubMed]
- Coolen, J.P.M.; Drijver, E.D.; Kluytmans, J.A.J.W.; Verweij, J.J.; Lamberts, B.A.; Soer, J.A.C.J.; Verhulst, C.; Wertheim, H.F.L.; Kolwijck, E. Development of an algorithm to discriminate between plasmid- and chromosomal-mediated AmpC β-lactamase production in Escherichia coli by elaborate phenotypic and genotypic characterization. J. Antimicrob. Chemother. 2019, 74, 3481–3488. [Google Scholar] [CrossRef] [PubMed]
- Thomson, K. Controversies about Extended-Spectrum and AmpC Beta-Lactamases. Emerg. Infect. Dis. 2001, 7, 333–334. [Google Scholar] [CrossRef]
- Oteo, J.; Bou, G.; Chaves, F.; Oliver, A. Microbiological methods for surveillance of carrier status of multiresistant bacteria. Enfermedades Infecc. Y Microbiol. Clin. 2017, 35, 667–675. [Google Scholar] [CrossRef]
- Jacoby, G.A. Extended-spectrum beta-lactamases and other enzymes providing resistance to oxyimino-beta-lactams. Infect. Dis. Clin. North Am. 1997, 11, 875–887. [Google Scholar] [CrossRef]
- Coudron, P.E. Inhibitor-based methods for detection of plasmid-mediated AmpC beta-lactamases in Klebsiella spp., Escherichia coli, and Proteus mirabilis. J. Clin. Microbiol. 2005, 3, 4163–4167. [Google Scholar] [CrossRef] [PubMed]
- Peter-Getzlaff, S.; Polsfuss, S.; Poledica, M.; Hombach, M.; Giger, J.; Böttger, E.C.; Zbinden, R.; Bloemberg, G.V. Detection of AmpC beta-lactamase in Escherichia coli: Comparison of three phenotypic confirmation assays and genetic analysis. J. Clin. Microbiol. 2011, 49, 2924–2932. [Google Scholar] [CrossRef] [PubMed]
- Kohner, P.C.; Robberts, F.J.L.; Cockerill, F.R.; Patel, R. Cephalosporin MIC distribution of extended-spectrum-{beta}-lactamase- and pAmpC-producing Escherichia coli and Klebsiella species. J. Clin. Microbiol. 2009, 47, 2419–2425. [Google Scholar] [CrossRef] [PubMed]
- Robberts, F.J.L.; Kohner, P.C.; Patel, R. Unreliable extended-spectrum beta-lactamase detection in the presence of plasmid-mediated AmpC in Escherichia coli clinical isolates. J. Clin. Microbiol. 2009, 47, 358–361. [Google Scholar] [CrossRef] [PubMed]
- Doi, Y.; Paterson, D.L. Detection of plasmid-mediated class C beta-lactamases. Int. J. Infect. Dis. IJID 2007, 11, 191–197. [Google Scholar]
- Yang, K.; Guglielmo, B.J. Diagnosis and treatment of extended-spectrum and AmpC beta-lactamase-producing organisms. Ann. Pharmacother. 2007, 41, 1427–1435. [Google Scholar] [CrossRef] [PubMed]
- Pfaller, M.A.; Segreti, J. Overview of the epidemiological profile and laboratory detection of extended-spectrum beta-lactamases. Clin. Infect. Dis. 2006, 42 (Suppl. 4), S153–S163. [Google Scholar] [CrossRef] [PubMed]
- Ingram, P.R.; Inglis, T.J.J.; Vanzetti, T.R.; Henderson, B.A.; Harnett, G.B.; Murray, R.J. Comparison of methods for AmpC β-lactamase detection in Enterobacteriaceae. J. Med Microbiol. 2011, 60, 715–721. [Google Scholar] [CrossRef] [PubMed]
- Haenni, M.; Châtre, P.; Madec, J.-Y. Emergence of Escherichia coli producing extended-spectrum AmpC β-lactamases (ESAC) in animals. Front. Microbiol. 2014, 5, 53. [Google Scholar] [CrossRef]
- Calvo, J.; Cantón, R.; Fernández Cuenca, F.; Mirelis, B.; Navarro, F. Available online: https://www.seimc.org/contenidos/documentoscientificos/procedimientosmicrobiologia/seimc-procedimientomicrobiologia39.pdf (accessed on 31 October 2021).
- Pitout, J.D.D. Extraintestinal pathogenic Escherichia coli: An update on antimicrobial resistance, laboratory diagnosis and treatment. Expert. Rev. Anti. Infect. Ther. 2012, 10, 1165–1176. [Google Scholar] [CrossRef]
- Martínez Rojas, D.D.V. Betalactamasas tipo AmpC: Generalidades y métodos para detección fenotípica. Rev. Soc. Venez. Microbiol. 2009, 29, 78–83. [Google Scholar]
- Polsfuss, S.; Bloemberg, G.V.; Giger, J.; Meyer, V.; Böttger, E.C.; Hombach, M. Practical approach for reliable detection of AmpC beta-lactamase-producing Enterobacteriaceae. J. Clin. Microbiol. 2011, 49, 2798–2803. [Google Scholar] [CrossRef] [PubMed]
- Tamma, P.D.; Doi, Y.; Bonomo, R.A.; Johnson, J.K.; Simner, P.J.; Antibacterial Resistance Leadership Group. A Primer on AmpC β-Lactamases: Necessary Knowledge for an Increasingly Multidrug-resistant World. Clin. Infect. Dis. 2019, 69, 1446–1455. [Google Scholar] [CrossRef] [PubMed]
- Edquist, P.; Ringman, M.; Liljequist, B.O.; Wisell, K.T.; Giske, C.G. Phenotypic detection of plasmid-acquired AmpC in Escherichia coli—evaluation of screening criteria and performance of two commercial methods for the phenotypic confirmation of AmpC production. Eur. J. Clin. Microbiol. 2013, 32, 1205–1210. [Google Scholar] [CrossRef]
- Black, J.A.; Thomson, K.S.; Pitout, J.D.D. Use of beta-lactamase inhibitors in disk tests to detect plasmid-mediated AmpC beta-lactamases. J. Clin. Microbiol. 2004, 42, 2203–2206. [Google Scholar] [CrossRef][Green Version]
- Black, J.A.; Thomson, K.S.; Buynak, J.D.; Pitout, J.D.D. Evaluation of beta-lactamase inhibitors in disk tests for detection of plasmid-mediated AmpC beta-lactamases in well-characterized clinical strains of Klebsiella spp. J. Clin. Microbiol. 2005, 43, 4168–4171. [Google Scholar] [CrossRef][Green Version]
- Willems, E.; Verhaegen, J.; Magerman, K.; Nys, S.; Cartuyvels, R. Towards a phenotypic screening strategy for emerging β-lactamases in Gram-negative bacilli. Int. J. Antimicrob. Agents 2013, 41, 99–109. [Google Scholar] [CrossRef]
- Navarro, F.; Calvo, J.; Cantón, R.; Fernández-Cuenca, F.; Mirelis, B. Detection of resistance phenotypes in gram-negative bacteria. Enferm. Infecc. Microbiol. Clin. 2011, 29, 524–534. [Google Scholar] [CrossRef]
- Seral, C.; Gude, M.J.; Castillo, F.J. Emergence of plasmid mediated AmpC β-lactamasas: Origin, importance, detection and therapeutical options. Rev. Esp. Quimioter. Publ. Of. Soc. Esp. Quimioter. 2012, 25, 89–99. [Google Scholar]
- Black, J.A.; Moland, E.S.; Thomson, K.S. AmpC disk test for detection of plasmid-mediated AmpC beta-lactamases in Enterobacteriaceae lacking chromosomal AmpC beta-lactamases. J. Clin. Microbiol. 2005, 43, 3110–3113. [Google Scholar] [CrossRef]
- Ampc Esbl Detection Set. Available online: https://mast-group.com/uk/products/amr/antibiotic-resistance-detection-sets/d68c/ (accessed on 25 October 2021).
- Etest® Para la Detección de Resistencia Antimicrobiana (ARD). bioMérieux España. Available online: https://www.biomerieux.es/diagnostico-clinico/productos/etestr-para-la-deteccion-de-resistencia-antimicrobiana-ard (accessed on 25 October 2021).
- Scapaticci, M.; Fossen, G.; Ius, V. Epidemiology of extended spectrum β-lactamase, AmpC and class A carbapenemases-producing organisms isolated at San Camillo Hospital of Treviso (Italy) between April 2012 and March 2014. Microbiol. Medica 2016, 31. Available online: https://www.pagepressjournals.org/index.php/mm/article/view/4622 (accessed on 10 February 2022). [CrossRef][Green Version]
- Fröding, I.; Vondracek, M.; Giske, C.G. Rapid EUCAST disc diffusion testing of MDR Escherichia coli and Klebsiella pneumoniae: Inhibition zones for extended-spectrum cephalosporins can be reliably read after 6 h of incubation. J. Antimicrob. Chemother. 2017, 72, 1094–1102. [Google Scholar] [PubMed]
- Dallenne, C.; Da Costa, A.; Decré, D.; Favier, C.; Arlet, G. Development of a set of multiplex PCR assays for the detection of genes encoding important beta-lactamases in Enterobacteriaceae. J. Antimicrob. Chemother. 2010, 65, 490–495. [Google Scholar] [CrossRef] [PubMed]
- Brolund, A.; Wisell, K.T.; Edquist, P.J.; Elfström, L.; Walder, M.; Giske, C.G. Development of a real-time SYBRGreen PCR assay for rapid detection of acquired AmpC in Enterobacteriaceae. J. Microbiol. Methods 2010, 82, 229–233. [Google Scholar] [CrossRef] [PubMed]
- Chavda, K.D.; Satlin, M.J.; Chen, L.; Manca, C.; Jenkins, S.G.; Walsh, T.J.; Kreiswirth, B.N. Evaluation of a Multiplex PCR Assay To Rapidly Detect Enterobacteriaceae with a Broad Range of β-Lactamases Directly from Perianal Swabs. Antimicrob. Agents Chemother. 2016, 60, 6957–6961. [Google Scholar] [CrossRef] [PubMed]
- Voets, G.M.; Fluit, A.C.; Scharringa, J.; Cohen Stuart, J.; Leverstein-van Hall, M.A. A set of multiplex PCRs for genotypic detection of extended-spectrum β-lactamases, carbapenemases, plasmid-mediated AmpC β-lactamases and OXA β-lactamases. Int. J. Antimicrob. Agents. 2011, 37, 356–359. [Google Scholar] [CrossRef]
- Geyer, C.N.; Reisbig, M.D.; Hanson, N.D. Development of a TaqMan Multiplex PCR Assay for Detection of Plasmid-Mediated AmpC β-Lactamase Genes. J. Clin. Microbiol. 2012, 50, 3722–3725. [Google Scholar] [CrossRef]
- Liu, Z.; Zhang, J.; Rao, S.; Sun, L.; Zhang, J.; Liu, R.; Zheng, G.; Ma, X.; Hou, S.; Zhuang, X.; et al. Heptaplex PCR melting curve analysis for rapid detection of plasmid-mediated AmpC β-lactamase genes. J. Microbiol. Methods 2015, 110, 1–6. [Google Scholar] [CrossRef]
- Caliskan, E.; Coskun, U.S.S.; Dulger, G.; Kilincel, O.; Ankarali, H.; Sahin, I. Investigation of plasmid mediated AmpC beta-lactamases in Escherichia coli and Klebsiella pneumoniae isolates by phenotypic and genotypic. J. Pak. Med Assoc. 2019, 69, 834–839. [Google Scholar]
- Kis, Z.; Tóth, Á.; Jánvári, L.; Damjanova, I. Countrywide dissemination of a DHA-1-type plasmid-mediated AmpC β-lactamase-producing Klebsiella pneumoniae ST11 international high-risk clone in Hungary, 2009–2013. J. Med. Microbiol. 2016, 65, 1020–1027. [Google Scholar] [CrossRef]
- Tenover, F.C.; Emery, S.L.; Spiegel, C.A.; Bradford, P.; Eells, S.; Endimiani, A.; Bonomo, R.A.; McGowan, J.E. Identification of Plasmid-Mediated AmpC β-Lactamases in Escherichia coli, Klebsiella spp., and Proteus Species Can Potentially Improve Reporting of Cephalosporin Susceptibility Testing Results. J. Clin. Microbiol. 2009, 47, 294–299. [Google Scholar] [CrossRef] [PubMed][Green Version]
- Agyekum, A.; Fajardo-Lubián, A.; Ai, X.; Ginn, A.N.; Zong, Z.; Guo, X.; Turnidge, J.; Partridge, S.R.; Iredell, J.R. Predictability of Phenotype in Relation to Common β-Lactam Resistance Mechanisms in Escherichia coli and Klebsiella pneumoniae. J. Clin. Microbiol. 2016, 54, 1243–1250. [Google Scholar] [CrossRef] [PubMed]
- Lee, K.; Hong, S.G.; Park, Y.J.; Lee, H.S.; Song, W.; Jeong, J.; Yong, D.; Chong, Y. Evaluation of phenotypic screening methods for detecting plasmid-mediated AmpC beta-lactamases-producing isolates of Escherichia coli and Klebsiella pneumoniae. Diagn. Microbiol. Infect. Dis. 2005, 53, 319–323. [Google Scholar] [CrossRef] [PubMed]
- Park, M.; Park, Y.-J.; Yu, J.; Lee, J.; Ahn, D.-R.; Min, S.-J. Performance of a novel fluorogenic probe assay for the detection of extended-spectrum-β-lactamase or plasmid AmpC β-lactamase–producing Enterobacterales directly from simulated blood culture bottles. J. Microbiol. Methods 2020, 175, 105988. [Google Scholar] [CrossRef] [PubMed]
- Song, W.; Bae, I.K.; Lee, Y.-N.; Lee, C.-H.; Lee, S.H.; Jeong, S.H. Detection of extended-spectrum beta-lactamases by using boronic acid as an AmpC beta-lactamase inhibitor in clinical isolates of Klebsiella spp. and Escherichia coli. J. Clin. Microbiol. 2007, 45, 1180–1184. [Google Scholar] [CrossRef] [PubMed][Green Version]
- Song, W.; Jeong, S.H.; Kim, J.-S.; Kim, H.-S.; Shin, D.H.; Roh, K.H.; Lee, K.M. Use of boronic acid disk methods to detect the combined expression of plasmid-mediated AmpC beta-lactamases and extended-spectrum beta-lactamases in clinical isolates of Klebsiella spp., Salmonella spp., and Proteus mirabilis. Diagn. Microbiol. Infect. Dis. 2007, 57, 315–318. [Google Scholar] [CrossRef] [PubMed]
- Pitout, J.D.D.; Le, P.G.; Moore, K.L.; Church, D.L.; Gregson, D.B. Detection of AmpC β-lactamases in Escherichia coli, Klebsiella spp., Salmonella spp. and Proteus mirabilis in a regional clinical microbiology laboratory. Clin. Microbiol. Infect. 2010, 16, 165–170. [Google Scholar] [CrossRef]
Publisher’s Note: MDPI stays neutral with regard to jurisdictional claims in published maps and institutional affiliations. |
© 2022 by the authors. Licensee MDPI, Basel, Switzerland. This article is an open access article distributed under the terms and conditions of the Creative Commons Attribution (CC BY) license (https://creativecommons.org/licenses/by/4.0/).